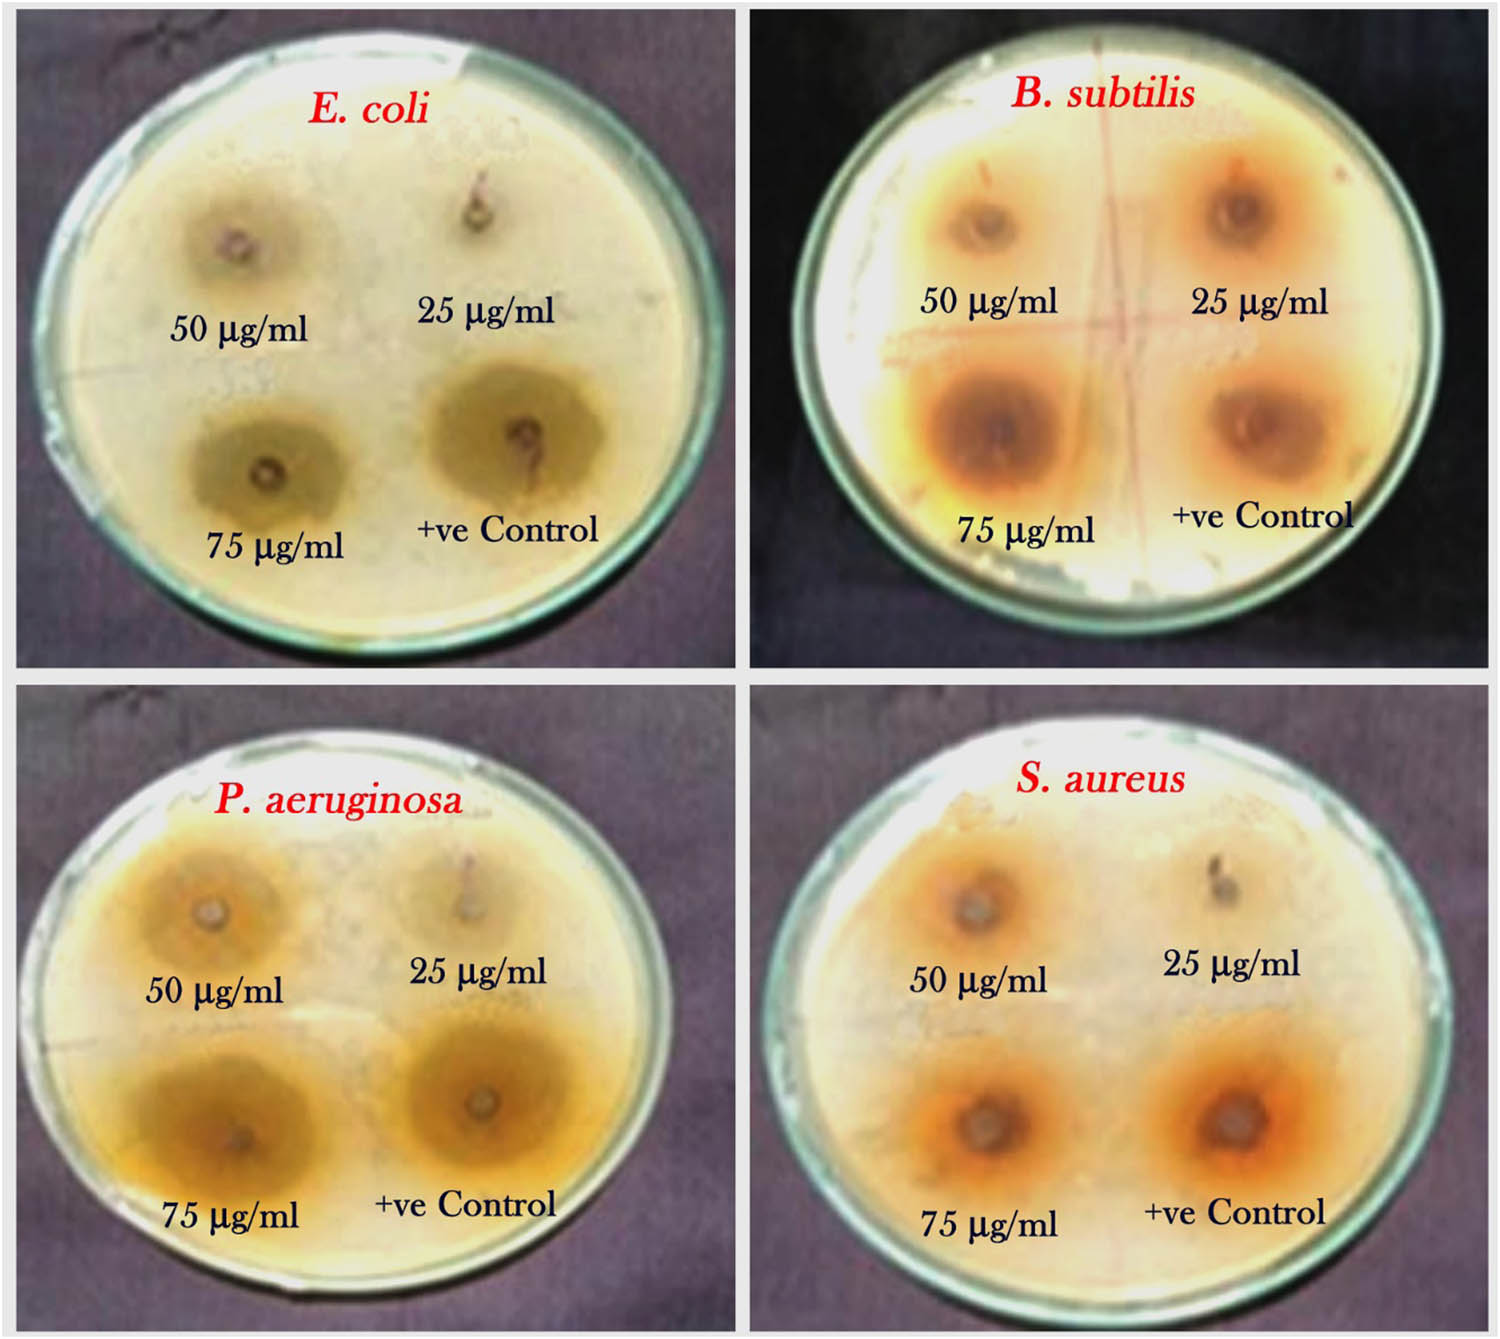
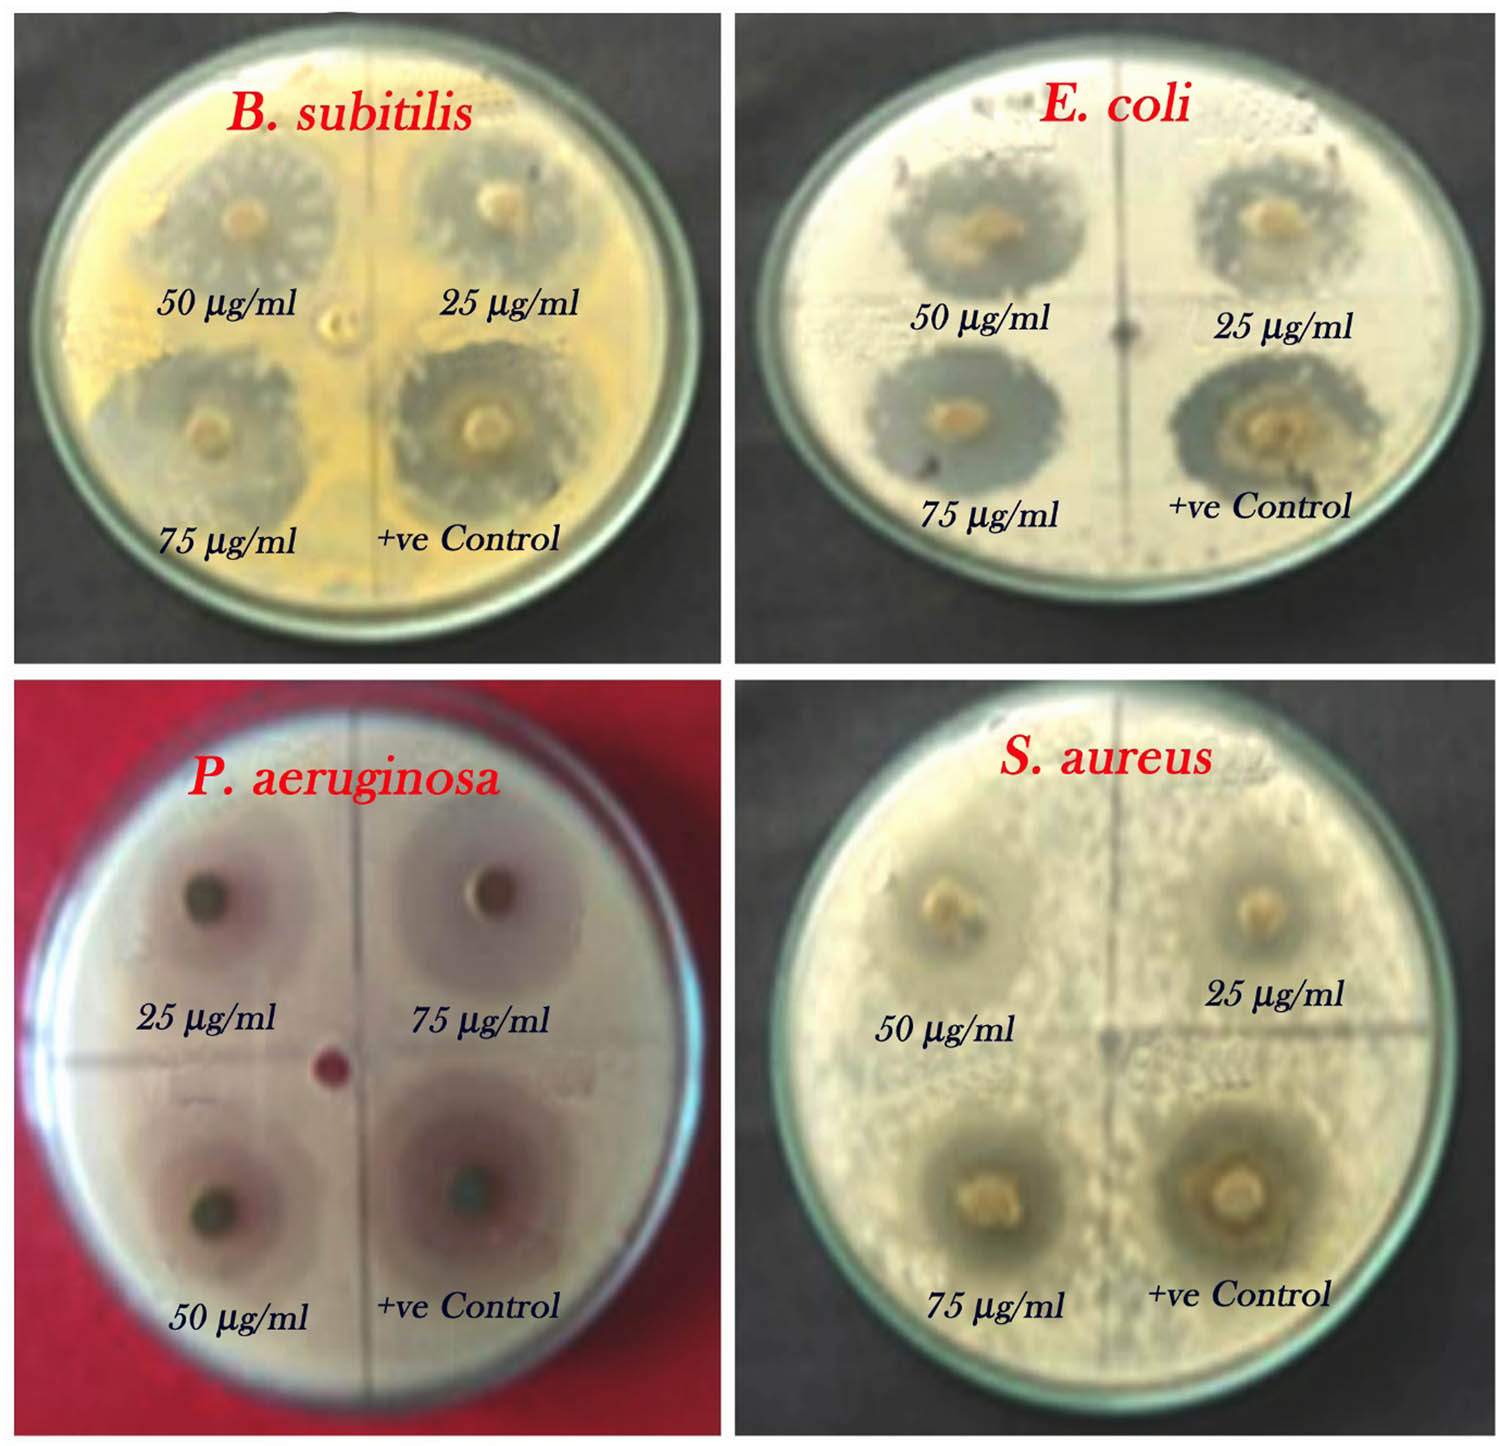

Synthesis of Lawsonia inermis-encased silver–copper bimetallic nanoparticles with antioxidant, antibacterial, and cytotoxic activity
-
Chinnasamy Ragavendran
, Devarajan Natarajan
Abstract
The extract of the medicinal plant Lawsonia inermis, known as henna, was employed to synthesize silver–copper bimetallic nanoparticles (Ag–Cu NPs) in a unique, efficient, and cost-effective method. The shape, size, and structural features of synthesized Ag–Cu NPs were determined by ultra–visible spectroscopy, Fourier transform infrared spectroscopy, X-ray diffractometer, field emission scanning electron microscopy, transmission electron microscopy, and energy dispersive X-ray spectroscopy methods. The rod-shaped Ag–Cu nanoparticles, averaging 41.66 ± 17.18 nm in size, synthesized from L. inermis, exhibited potent antioxidant activity by inhibiting 2,2-diphenyl-1-picrylhydrazyl and 2,2′-azinobis (3-ethylbenzothiazoline-6-sulfonic acid) free radicals. They also displayed significant antibacterial effects against Pseudomonas aeruginosa (28 mm), Staphylococcus aureus (27 mm), Bacillus cereus (26 mm), and Escherichia coli (24 mm). Additionally, these nanoparticles induced notable morphological changes in cancer cells and demonstrated promising cytotoxicity against MDA-MB-231 tumor cells (IC50 = 37.40 µg·mL−1). However, they exhibited biotoxicity in Artemia nauplii, resulting in mortality rates ranging from 3.0% to 32.5%. The LC50 and LC90 values recorded for a 48-h exposure were 1.51 mg·L−1 and 2.59 mg·L−1, respectively. These findings highlight the potential application of L. inermis-derived Ag–Cu NPs in pharmacology and bio-nanomedicine.
Graphical abstract

1 Introduction
Nanotechnology is considered useful in fields of modern technology, such as health [1], pharmaceutical [2], and ecology [3]. The cornerstone of nanoscience lies in the creation of innovative molecules or nanoparticles [NPs] through techniques centered around auto-assembly [4]. Nanomaterials have demonstrated applications in the development of oral, transdermal, widespread, pulmonary, and other delivery techniques to facilitate drug transport, increase therapeutic bioavailability, and ensure medicine biocompatibility [5], including the utilization of NPs as catalysts [6]. In particular, NPs produced by noble metals, including gold, silver, platinum, and zinc, are utilized in medicinal and consumer applications [7]. However, NPs are regarded as chemical risks. In fact, they may combine with and absorb organic compounds [8].
Silver nanoparticles (AgNPs) have shown potentials in the pharmacy sector [9]. AgNPs are used in the production of disinfection lotions and dressings for burns and wounds [10,11]. Additionally, they could be used as visual components, such as fluorescent equipment and bioimaging devices [12]. AgNPs have an extensive choice of applications in biomedicine because of their distinct properties, including antibacterial, antifungal [13,14], anti-inflammatory [15], anti-angiogenesis [16], antiviral agent [17], and anti-platelet effects, among others [18,19].
The advantages of plant-based sustainable nanoparticle synthesis over chemical methods have been repeatedly demonstrated by recent study [20]. A viable and eco-friendly method for producing metal and metal oxide NPs, among other nanomaterials with a variety of uses, is called “green synthesis.” Sustainable synthesis from plants yields non-toxic and biocompatible NPs, making it a safe and environmentally acceptable substitute for chemical processes, especially in the context of medical applications [21]. Green fabrication of the metal NPs is produced by the utilization of chemical compounds of plant extracts [22]. The inexpensive, less hazardous, and easily scalable single-step green synthesis processes, on the other hand, are quick, sustainable, and environmentally friendly [23]. Applications for metal NPs, including gold, silver, and platinum, are widely used and provided top priority in the bioimaging, photochemical, electrochemistry, and cosmetic sectors. Green synthesis approaches are used because they have the ability to minimize the toxicity of NPs [24]. The monometallic NPs were shown to possess antibacterial abilities as well as anti-plasmodial, anticancer, pesticidal, and larvicidal effects [25,26]. However, as compared to their monometallic counterparts, the combinatorial synthesis of various mixtures of bimetallic nanoparticles (BNPs) is recognized to have unique features. Investigation into the various BNPs might reveal special characteristics regarding their antagonistic or synergistic multifunctional action [27,28,29]. The growth in the use of hybrid composites has accelerated because of their extensive wide range of applications, which include water purification, antibacterial characteristics, and photocatalysis [30,31]. The plant components not only function as a strong reducing agent but also assist in the formation of steady NPs through their capping activity. The metal silver is now widely utilized as a protective coating for NPs in several areas of biosensors and antibacterial applications in medicine. It demonstrated notable characteristics, including non-toxicity, biodegradability, and biocompatibility [22]. This article reports the synthesis of NPs containing L. inermis L. aqueous extract. This plant is worldwide known for its use in temporary tattoos and as a medicinal plant, under the names of the derived products henna or henné. The phytochemical studies revealed a complex chemical constitution of L. inermis, including phenolic, tartaric, citric acids, anthraquinones, stilbenoids, polyphenols, triterpenes, carotenoids, naphthalene, and other constituents, including hennosides, the glucosidic precursors of lawsone, which is the dying ingredient [32]. The majority of these constituents, notably organic acids, function as strong reducers.
In the synthesis of AgNPs using phytochemicals, there are three phases. First, the precursor Ag+ is reduced to Ag by constituents of the plant extract. Then, the produced Ag atoms develop NPs, and the newly manufactured AgNPs enlarge as a result of the surface reduction of the Ag+ ion. Finally, the AgNP’s size is controlled by electrostatic stabilization, and plant extract’s negatively charged ionic species adhere to the surface of the AgNPs, triggering capping [33].
The study aimed to synthesize for the first time bimetallic (Ag–Cu) nanoparticles using L. inermis leaf extract. The resulting Ag–Cu NPs were characterized by various methods (ultra–visible spectroscopy [UV–Vis], Fourier transform infrared spectroscopy [FTIR], X-ray diffractometer [XRD], field emission scanning electron microscopy [FESEM], and transmission electron microscopy [TEM]), and the antioxidant, antibacterial, and antiproliferative activities were assessed. Furthermore, the biotoxicity was determined. In ecotoxicological studies that screen several metabolites for drug detection in plants, the A. nauplii assay is routinely used [34]. Artemia-based assays are considered quick, convenient, and affordable.
2 Materials and methods
2.1 Chemical
The following chemicals were purchased from Hi-Media (Mumbai, India): 3-(4,5-dimethylthiazol-2-yl)-2,5-diphenyltetrazolium bromide (MTT), 2,2-diphenyl-1-picrylhydrazyl (DPPH), 2,2′-azinobis (3-ethylbenzothiazoline-6-sulfonic acid) (ABTS), and dimethyl sulfoxide (DMSO). All other chemicals were of excellent purity and analytical quality and obtained from Bio Corporals, Chennai, Tamil Nadu.
2.2 Collection and preparation of leaf extract
L. inermis L. fresh leaves were collected in Idappadi (latitude: 11.5849° N, longitude: 77.8382° E), Salem, Tamil Nadu. Botanical voucher samples were deposited in the Periyar University, Natural Drug Research Laboratory (NDRL). The leaves were thoroughly cleaned under running water, allowed to dry at room temperature, and then cut into small pieces to remove any remaining debris. Dr. D. Natarajan, Associate Professor in the Department of Biotechnology at Periyar University in Salem, identified the plant. The fresh leaves were thoroughly washed with distilled water and then allowed to air dry in the shade at room temperature. The dried leaves were ground using an electric lab grinder into a well powder. The prepared fine powder (10 g) was mixed with distilled water (100 mL), and the combination was heated for 30 min at 80°C, while being continually stirred. Whatman filtration paper No. 1 was used to filter the obtained material. The extract was stored until necessary at 4°C [34].
2.3 Preliminary phytochemical analysis
The freshly obtained n-hexane, methanol, ethyl acetate, and aqueous extracts of L. inermis leaves were subjected to phytochemical analysis to identify the presence of several phytoingredients, including phenol, terpenoids, flavonoids, tannins, saponins, and alkaloids (Table 1) by the standard methodology reported by Balaei-Kahnamoei et al. [35]. The results are in accordance with previous reports [32] and with different polarities of the constituents.
Qualitative phytochemical analysis of different extracts of L. inermis
S. no. | Test | n-Hexane | Ethyl acetate | Methanol | Water |
---|---|---|---|---|---|
1 | Alkaloids | + | + | − | − |
2 | Phenol | − | + | + | + |
3 | Flavonoids | + | + | + | + |
4 | Steroids | + | + | + | − |
5 | Terpenoids | + | + | + | − |
6 | Saponins | − | − | + | + |
7 | Glycosides | − | + | + | + |
8 | Tannins | − | − | − | + |
‘−’ indicates absence, “+” indicates presence.
2.4 Biosynthesis of Ag–Cu NPs
Ag–Cu was used as a precursor material in the nanoparticle’s synthesis. The bimetal nanoparticles were weighed (2 mM of silver nitrate [AgNO3], Sigma Aldrich and copper acetate [0.2 M of CuCO2CH3, Sigma Aldrich]) and added to 1,000 mL of the plant extract. Then, the aqueous extract (10 g of plant leaf powder mixed with 100 mL of sterile distilled water) was added to the metal solution. Aqueous extract and metal solution were combined in a 1:1 ratio. The metal solution (Ag–Cu) was added along with 500 mL of L. inermis leaf extract and mixed using a magnetic stirrer for 1 h. The mixture was kept in a magnetic stirrer under vigorous agitation at 60°C for a further 3 h. The solution was allowed to stand overnight at room temperature. After this process, a yellowish-brown color was observed. Then, the mixture was centrifuged at 12,000 rpm for 15 min and the sediment was dissolved in distilled water. The pellet was stirred at 12,000 rpm for 20 min along with milli-Q-water. The pellet/sediment was transferred into the Petri plate. After the plate was dried using a hot air oven. Then, the plate was kept in a drier for 2 days. Finally, the dried nanopellets were stored in an airtight container and kept at 4°C until further use [36].
2.5 Characterization of Ag–Cu NPs
A UV–Vis spectrophotometer (Systronics, 2302, India) was used for the preliminary detection of Ag–Cu NPs. After agitating and maintaining the pH, the solution was scanned from 300 to 700 nm. Functional groups at distinct wavenumbers in L. inermis, as well as the resulting solution of Ag–Cu NPs, were evaluated using FTIR Bruker ATR Alpha-II (Bruker, India) in a range from 4,000 to 500 cm−1 [37]. The phase and crystalline nature of the fabricated Ag–Cu NPs were examined using XRD. Cu K energy with a spectrum of 1.5 Å at 40 kV and 30 mA was used for the evaluation on an X-ray diffractometer (Bruker, Germany) with a scanning frequency of 0.02 cm−1 in the area of 2θ extending between 10° and 90° [35]. The morphology, shape, and atomic constituents of metallic elements in fabricated Ag–Cu NPs were investigated using FESEM combined with energy dispersive X-ray spectroscopy (EDX). Using double-sided tape, the samples were secured to the tubular aluminum stub. The samples supported by stubs had a gold coating. A scanning electron microscope (EVO 18, ZEISS) with a 10,000× magnification was used to evaluate the surface morphology of the gold-coated samples [38]. TEM analysis was used to categorize the NPs based on their size and form. Following the synthesis of Ag–Cu NPs, a small quantity of the sample was released onto a copper grid that had been covered with carbon. The excess solution was eliminated using tissue paper, and the grid’s film was left to dehydrate under a mercury lamp for 6 min. The picture was then enlarged at various magnifications to observe Ag–Cu NPs. The instrument’s software was used to examine the data. Subsequently, a JEOL JEM-2100 TEM (JEOL, Tokyo, Japan) was used to scan the grid at a voltage of 120 kV. The surface charge of the produced Ag–Cu NPs was estimated using zeta potential analysis, which served as a standard for the NPs’ physical stability. After preparing the sample solution in distilled water and ultrasonically sonicating it twice or three times, it was centrifuged for 15 min at 5,000 rpm. The dispersed solution exhibited a viscosity of 0.875 mPa s. Subsequently, the conductivity was fine-tuned to 0.130 mS·cm−1, and the electric voltage was set at 3.4 V for the nano-analyzer apparatus (Horiba Scientific Nanoparticle Analyzer SZ-100, Kyoto, Japan) [39].
2.6 Antibacterial activity
The antibacterial efficacies of the Ag–Cu NPs and the aqueous extract of L. inermis were examined using four strains, such as Staphylococcus aureus (ATCC 25923), Escherichia coli (ATCC 25922), Bacillus subtilis (MTCC 1272), and Pseudomonas aeruginosa (MTCC 1035). They were periodically sub-cultured in the lab and kept in nutritional agar slants. For the production of the inoculums, a single colony was cultured overnight in nutrient broth, and the turbidity was subsequently adjusted to 0.5 McFarland standards. The experiment strains were swabbed onto Mueller Hinton agar (MHA) dishes and left to air dry for 10 min. Three distinct amounts (25, 50, and 75 µg·mL−1) were used. Chloramphenicol (5 µg·mL−1) served as the positive reference. After 24 h at 37°C, the area of inhibition on the plates was determined and tabulated. The results were obtained by calculating the zones of growth inhibition (mm), as described by Kiani et al. [40].
2.7 Antioxidant assay
2.7.1 DPPH scavenging assay
The DPPH scavenging procedure was used to assess the antioxidant properties of the Ag–Cu NP containing aqueous leaf extract of L. inermis [41]. Briefly, 100 µL of different Ag–Cu NP doses, plant extract, and reference (ascorbic acid) (25–150 µg·mL−1) were combined with 100 µL of DPPH (0.1 mM in 80% ethanol) and kept for 30 min at 37°C in dark conditions. The intensity of the response solution was read at 517 nm against a blank (80% ethanol) using a spectrophotometer (Shimadzu1601 model, Japan). The % of DPPH scavenging free radicals was calculated using Eq. 1.
where A0 is the absorbance of the control, and A1 is the absorbance of the test.
2.7.2 ABTS assay
The ABTS radical ability of various amounts of aqueous extract and Ag–Cu NPs was measured using a proven methodology. ABTS (7 mM) and potassium persulfate (2.45 mM) were combined to produce the stock solution, which was then kept at RT in the dim for 16 h. Then, the stock ingredient was diluted with methanol to produce the working solution, which had a 734 nm absorbance. Then, 25–150 µg·mL−1 of different water extract and Ag–Cu NP concentrations were added to 180 µL of the ABTS test solution. Using a spectrophotometer (Shimadzu1601 model, Japan), the optical density (OD) at 734 nm was recorded after 30 min at ambient temperature. Ascorbic acid functioned as the standard. Formula 1 was used to estimate the % of free radicals that ABTS was able to scavenge [38]. Percent inhibition of absorbance at 734 nm was calculated using Eq. 2:
where AB is the absorbance of ABTS radical + methanol and AA is the absorbance of ABTS radical + sample extract/standard. Ascorbic acid was used as a standard substance.
2.8 Culturing of cancerous cells
The cytotoxicity effects of fabricated Ag–Cu NPs were evaluated using the breast cancer (BC) cells (MDA-MB-231). The cells were grown in Dulbecco’s modified Eagle’s medium with 10% fetal bovine serum (FBS) and 1% penicillin–streptomycin in a CO2 atmosphere with 5% CO2. Trypan blue was used to determine the number of cells and the live cells in a hemocytometer. The cells were seeded at 1 × 104 in a 96-well plate and placed in the CO2 incubator for 24 h at 37°C for the MTT evaluation.
2.8.1 Assessment of cytotoxic effects on cancer cells
The bimetallic synthesized Ag–Cu NPs were investigated in the MDA-MB-231 cells at different concentrations (25, 50, 75, and 100 µg·mL−1). The dilutions were obtained using DMSO. The cells received treatment and were then placed in a CO2 incubator for 24 h. After a microscope observation of the cell morphology after 24 h, 20 µL of the MTT solution (5 mg·mL−1) was added, and the mixture was then maintained for 4 h at 37°C. About 100 µL of DMSO was added after incubation to help in thawing the formazan that had been produced. In order to measure the cell viability, the OD at 570 nm was calculated via a 96-well plate reader.
2.8.2 AO/EB dual staining
Ag–Cu NP-treated cells were exposed to acridine orange/ethidium bromide (AO/EB) double labeling to look for structural signs of death. To stain 25 µL of treated and untreated cells (5 × 106 cells·mL−1), AO/EB dye combination (100 mg·mL−1 generated in PBS noticeably) was used. After that, fluorescence microscopy (Nikon Eclipse TS 100) was used to evaluate the samples [42].
2.9 Toxicity testing by A. nauplii
A. nauplii cysts were obtained at the Central Institute of Brackishwater and Aquaculture (CIBA, Chennai, Tamil Nadu). The synthetic saline water was produced by adding 35 g of NaCl in 1 L of purified water, and dehydrated cysts were then immersed in the solution. After 48 h of incubating at room temperature (28 ± 2.0°C) with active oxygenation and continuous light, the nauplii hatched within 48 h [34].
The toxicity of NPs in A. nauplii was evaluated using the previous procedures [43]. The test was conducted on brine shrimp larvae (A. nauplii). For the production of a standard solution, 50 mg of NPs were placed in suspension in 1 mL of distilled water. The freshly prepared suspension with various amounts of NPs (2, 4, 6, 8, and 10 mg·L−1) was then arranged by serial dilution of the stock solutions of NPs in synthetic saline water (35 g·L−1) instantly before use. The 24-well microtiter plates were filled with 2 mL of a solution (different NP amounts). The 24-well plates were then filled with 10 nauplii each, and they were left to develop for 24 h at 37°C. After 24 h, the quantity of nauplii that survived in the respective well was recorded using a stereo microscope. For each concentration, the experiment was performed in triplicate. Only ten nauplii and prepared brine water were found in the negative control wells. The % of mortality was estimated by comparison of the amounts of survival in the test and control experiment help. The lethality was measured according to Abbott’s formula:
2.10 Statistical analysis
GraphPad Prism was used to perform a grouped analysis of variance (ANOVA) on the data (GraphPad Software, San Diego, California, USA). Between the treatment and control sets, a P < 0.05 was considered significant. The findings of experiments were stated as mean ± SD.
3 Results
3.1 Phytochemical analysis of L. inermis
The antibacterial activity of plants is mostly attributed to secondary metabolites, including tannins and phenolic compounds. Phytochemical analyses were carried out to determine the metabolites contained in the various L. inermis extracts. Table 1 shows that the aqueous, methanol, and acetone extracts all included cardioglycosides, terpenoids, carbohydrates, phenols, and quinones. All four of these extracts lacked significant amounts of proteins. The methanol extract also contained tannins, cardioglycosides, carbohydrates, phenols, and quinones, but not alkaloids or terpenoids, at least not in concentrations that could be detected. These metabolites dissolve in the solvent based on their polarity.
3.2 UV–Vis spectroscopic examination
Color changes were noticed by pictorial analysis of the L. inermis leaf extract of the synthesized Ag–Cu NP solution. The L. inermis leaf extract alone does not result in any changed color. When the plant extract was added to the Ag–Cu solution, the color changed to light brown (in an hour), and 24 h later, it changed to light green (Figure 1). Ag–Cu NPs produced from the L. inermis leaf extract were absorbed in the UV spectrum at different wavelengths between 200 and 600 nm. The peak of Cu NPs is 295 nm, the highest wavelength of AgNPs is 415 nm, and the peak of Ag–Cu NPs is 455 nm (Figure 2).

Fabrications of bimetallic Ag–Cu NPs from L. inermis. (a) Aqueous leaf extract of L. inermis. (b) 2 mM silver nitrate (AgNO3), (c) 0.2 M copper acetate, and (d) color shift of the extract from light brown to light green after development at room temperature (synthesized Ag–Cu NPs).

UV spectrum of the Ag, Cu, and Ag–Cu NPs fabricated from the L. inermis.
3.3 FTIR analysis of Ag–Cu NPs
The synthesized Ag–Cu NPs were subjected to FTIR spectroscopy, which demonstrated the presence of multiple functional groups at various wavelengths in the range of 3,234.89, 2,914.29, 2,847.92, 1,724.04, 1,595.07, 1,352.79, 1,010.91, and 627.68 cm−1. These groups were associated with carboxylic acid, alkanes, aldehyde, carboxylic acid, aromatic acids, nitro, and ether. The significant absorption peak of Ag–Cu NPs, which was detected at 3,234.89 cm−1, indicates that there is more carboxylic acid with O–H stretches involved. On the other hand, compounds containing alkanes are allocated the C-H stretching vibration of one band at 2,914 cm−1. There is aldehyde with C–H stretches present, as indicated by the peak at 2,847.92 cm−1. The dense band at 1,010 cm−1 is ascribed to the –C–O of ether found in coumarins, while the signatures at 1,724.04 cm−1 are caused by the distinctive peaks of coumarins (biomolecules responsible for reduction). The spectrum of absorption at 1,595 cm−1 is evidence of the stretching vibration of amines (N–H) in proteins. The value observed at 1,352.79 cm−1 denoted nitro with N═O stretches. The smaller concentration signal at 627.68 cm−1 provides chloride with C–Cl stretching. The corresponding assignments to functional groups are reported in Table 2 and Figure 3. In summary, the FTIR analysis demonstrates that L. inermis contains proteins, amino acids, alcohols, and metabolites that include carboxylic acids. These substances may have served as stabilizing and reducing mediators while Ag–Cu NPs were being formed.
FTIR analysis of Ag–Cu NPs synthesized using L. inermis
S. no. | Wavenumbers (cm−1) | Stretch/bonding | Functional groups | Visible intensity |
---|---|---|---|---|
1. | 3,234 | O–H bonded | Phenolic groups | Broad |
2. | 2,914 | C–H stretch | Alkanes | Medium |
3. | 2,847 | C–H stretch | Aldehyde | Medium |
4. | 1,724 | C═O stretch | Carboxylic acid | Medium |
5. | 1,595 | N–H stretch | Primary amine | Strong |
6. | 1,352 | N═O stretch | Nitro | Broad |
7. | 1,010 | C–O stretch | Ether | Strong |

FTIR spectra of the biosynthesis of Ag–Cu NPs fabricated from L. inermis aqueous extract.
3.4 X-ray diffraction analysis
The XRD pattern study proved the crystalline aspects of the Ag–Cu NPs (Figure 4). The most intense peak was observed at 32.12°, 38°, 44°, and 77.30°. This confirmed the position of the Ag–Cu nanocrystals as the peak positions at 2θ (43.21°, 54.10°, and 75.10°) were indexed to the normal planes of Ag–Cu nanocrystals. These planes showed that copper metal face-centered cubic (FCC) in its structure. These high-pitched Bragg peak strengths have been confirmed due to the stabilization of the Ag–Cu NPs. The XRD pattern of fabricated Ag–Cu NPs shows five strongest peak values at (32.12°), (38°), (44°), (64.41°), and (77.30°) which is corresponding to the intense count (IC).

XRD analysis of the biosynthesis of Ag–Cu NPs fabricated from the L. inermis.
3.5 FESEM and EDX analysis
The FE-SEM micrograph provided further information about the morphological characteristics of the particles synthesized. The average size of acquired Ag–Cu NPs is 41.66 nm. The scanning electron micrograph of the NPs at 123× magnification is shown in Figure 5a–e. The EDX findings confirmed that the Ag–Cu NPs are the source of the metals Ag and Cu, with a 51.7% atomic proportion. Other maxima in the EDX were seen in addition to Ag, C, Cu, and O, each having an atomic proportion of 47.6%, 23.4%, 4.1%, and 25.0%, respectively. The oxygen single was produced from the absorbed parts of the leaf extract and the device’s coating. In contrast to Ag, Cu, and indicated the production of pure Ag–Cu NPs, all other elements, with the exception of carbon, have a very low atomic amount (Figure 5F). The zeta potential was used to examine the stability of the nanoparticle in the aqueous solution and its surface charge potential. The zeta potential of the produced Ag–Cu NPs revealed good stability with a strong peak at −21.0 mV (Figure 5g).

Electron microscopy study: (a) FESEM analysis, (b–d) TEM analysis of Ag–Cu NPs, (e) particle size distribution, (f) EDX spectra of Ag–Cu NPs, and (g) zeta potential analysis of synthesized Ag–Cu NPs from leaf extract of L. inermis.
3.6 Antibacterial activity
The three different concentrations of L. inermis aqueous extract and Ag–Cu NPs (25, 50, and 75 µg·mL−1) were tested for antibacterial activity against selected pathogens using the agar well diffusion method. The antibacterial activity of leaf extract from L. inermis was compared to a positive reference (chloramphenicol, 5 µg·mL−1). The inhibitory zones are presented in Figures 6 and 7 and Tables 3 and 4. At 75 µg·mL−1 concentration, the maximum concentration of leaf extract showing the highest growth inhibition was observed, such as E. coli (19 mm), B. subtilis (23 mm), P. aeruginosa (26 mm), and S. aureus (16 mm). Strong antibacterial properties were demonstrated by synthesized Ag–Cu NPs against the targeted human pathogens. The results revealed that P. aeruginosa and S. aureus had the maximum inhibition zones, measuring 25 mm, followed by E. coli, which had the second-largest zones, measuring 22 mm, and B. subtilis, which had the lowest zones, measuring 20 mm. Overall, these results demonstrated that the presence of strong bioactive components may affect the antibacterial properties of plant substances. The antimicrobial activities of produced Ag–Cu NPs covered with bioactive plant compounds may effectively control new bacterial strains, including multidrug-resistant strains, based on the results of this experiment. According to the results, the antibacterial activity of nanomaterials depends mostly on their size and concentration, and it is more evident against Gram negative than Gram positive pathogens. Ag–Cu NPs are strongly effective against human pathogens, which leads to the capability of the Ag–Cu NPs to inhibit bacterial growth. The growth of inhibition was validated for each of the pathogens and recorded.
Antibacterial activity of L. inermis aqueous extract tested against human clinical pathogens at different concentrations.
Antibacterial activity of synthesized Ag–Cu NPs tested against human clinical pathogens.
Antibacterial activity in L. inermis plant extract against clinical pathogens
Concentration of aqueous extract (µg·mL−1) zone of inhibition (mm) | |||||
---|---|---|---|---|---|
S. no. | Pathogens | 25 | 50 | 75 | Chloramphenicol |
1. | B. subtilis | 12.0 ± 1.0 | 14.0 ± 0.5 | 16.0 ± 0.5 | 19.0 ± 1.0 |
2. | E. coli | 13.5 ± 1.5 | 16.5 ± 1.0 | 19.5 ± 0.5 | 23.5 ± 0.5 |
3. | P. aeruginosa | 14.0 ± 1.2 | 18.2 ± 1.5 | 22.0 ± 0.5 | 26.0 ± 0.5 |
4. | S. aureus | 10.5 ± 0.0 | 12.2 ± 1.0 | 14.5 ± 1.0 | 16.5 ± 1.0 |
Antibacterial activity of Ag–Cu NPs tested against human pathogens
Concentration of Ag–Cu NPs (µg·mL−1) zone of inhibition (mm) | |||||
---|---|---|---|---|---|
S. no. | Pathogens | 25 | 50 | 75 | Chloramphenicol |
1. | B. subtilis | 14.0 ± 0.07 | 17.0 ± 0.14 | 20.0 ± 0.14 | 24.5 ± 0.12 |
2. | E. coli | 16.4 ± 1.04 | 19.0 ± 0.63 | 22.0 ± 0.49 | 26.5 ± 0.43 |
3. | P. aeruginosa | 17.0 ± 0.63 | 21.5 ± 0.52 | 25.5 ± 0.82 | 28.0 ± 0.11 |
4. | S. aureus | 18.5 ± 0.82 | 22.0 ± 0.93 | 25.0 ± 0.29 | 27.5 ± 0.46 |
3.7 Antioxidant activity using DPPH and ABTS assay
DPPH and ABTS evaluations were used to determine the radical potential of the aqueous extract of L. inermis and Ag–Cu NPs. Using ascorbic acid as a reference, the analyses demonstrated that the tested sample increased the scavenging ability of DPPH (Figure 8a) and ABTS radicals (Figure 8b) in a concentration-dependent pattern. The Ag–Cu NPs had a better free radical inhibition rate with 90.5 and 85.24 μg·mL−1 as associated with the extract with 70 and 68 µg·mL−1 using DPPH and ABTS, respectively. The capacity of the nanomaterials to quench neutral and cationic radicals was evaluated, and the result showed that Ag–Cu NPs were effective against both constant unbiassed radicals produced by DPPH and free cationic radicals generated via ABTS.

Scavenging activity of various amounts of the aqueous leaf extract of L. inermis and Ag–Cu NPs using (a) DPPH assay and (b) ABTS assay.
3.8 Evaluations of cytotoxicity on BC cells
To investigate the cytotoxic effects of the environmentally produced Ag–Cu NPs, MDA-MB-231 cancer cells were treated with varying concentrations of NPs for 24 h. The MTT assay results demonstrate that cell viability gradually decreases when Ag–Cu NP concentration increases in MDA-MB-231, which were determined to be 37.40 µg·mL−1, respectively. The cell appearance was examined using an inverted microscope at the IC50 concentration of Ag–Cu NPs. Based on the findings of the cytotoxic activity investigation, the researchers can conclude that the biosynthesized Ag–Cu NPs are 100 µg·mL−1 hazardous to MDA-MB-231 cells, as depicted in Figure 9. The study's findings indicate that the cytotoxicity of phyto-synthesized Ag–Cu NPs increased with nanoparticle concentration.

Morphological sign of apoptosis by AO/EB dual staining. (a) Untreated cells (control); (b) cells exposed to synthesized Ag–Cu NPs of L. inermis show unchanged morphology; (c) untreated cells (control) appear to be systematically green with a normal framework; and (d) cells treated (100 µg·mL−1) with Ag–Cu NPs displays apoptotic bodies and disorganized nuclei (400× magnification). (e) The percentage of living cells among MDA-MB-231 human breast cancer cells, as well as apoptotic and necrotic cells, after 24 h of treatment with synthesized Ag–Cu NPs from L. inermis.
3.9 Morphological sign of cancer cells
The AO/EB double staining method was used to observe the apoptosis-related structural changes induced by both Ag–Cu NPs. The stained cells were classified as follows: alive (light green) (Figure 9c), primary apoptotic (bright green color with packed chromatin), late apoptotic (orange color), or completely unviable (fluorescence of red color) (Figure 9d). Cells exposed to Ag–Cu NPs displayed cytotoxic bodies, membrane blebbing, and contracted nuclei. The nuclear framework of the control cells, however, was undamaged.
3.10 Toxicity to A. nauplii
The primary assessment of the environmental toxicity of chemicals and other substances can be obtained through ecotoxicological investigations using microcrustaceans such as brine shrimp. Based on the present study, mortality rates have been determined for exposure to different Ag–Cu NP concentrations for 24 and 48 h. The lethality assays using brine shrimp produced the LC50 and LC90 values of the Ag–Cu NPs synthesized from L. inermis (Table 5). A. nauplii mortality was noticed in all doses, as shown in Figure 10, and was more pronounced at the concentration of 10 mg·L−1. The LC50 and LC90 values of Ag–Cu NPs synthesized against A. nauplii larvae treatments were better (3.58, 5.83 mg·L−1 for 24 h and 1.51, 2.59 mg·L−1 for 48 h). The aquatic behavior of A. nauplii larvae exposed to Ag–Cu NPs at the highest concentration (10 mg·L−1) was significantly changed, and the following alterations were noticed: disruption and change of behavior, which predominantly resulted in reduced swimming ability, feeding (Figure 10c). Furthermore, body damages, such as thorax swelling, appendages loss, and antennal disfigurement (treated), were observed. In control tests, all nanoparticle doses had no lethal impact on A. nauplii after 24 h of exposure (Figure 10d). Overall, the results indicate that the mortality rate increased with fabricated nanomaterials and exposure duration.
Non-target toxicity assay of Artemia nauplii lethality using Ag–Cu NPs at 24 and 48 h exposure
Concentrations (mg·L−1) | Percentage of mortality | LC50 (LCL−UCL)(mg·L−1) | LC90 (LCL−UCL) (mg·L−1) | χ2 (df = 13) |
---|---|---|---|---|
24 h | ||||
2.0 | ||||
4.0 | 3.0 ± 0.5 | 3.58 (2.631–4.331) | 5.834 (4.940–6.762) | 3.726 |
6.0 | 5.5 ± 1.0 | |||
8.0 | 7.0 ± 1.5 | |||
10 | 12.5 ± 1.2 | |||
Control | 18.0 ± 1.0 | |||
0.0 ± 0.0 | ||||
48 h | ||||
2.0 | 9.0 ± 0.5 | 1.514 (0.919–2.052) | 2.592 (1.872–3.191) | 9.107 |
4.0 | 12.5 ± 1.0 | |||
6.0 | 14.5 ± 1.5 | |||
8.0 | 24.0 ± 1.0 | |||
10 | 32.5 ± 0.5 | |||
Control | 0.0 ± 0.0 |

Visible abnormalities in Artemia nauplii exposed to various Ag–Cu NP amounts. (a) A. nauplii in the control was not subjected to any NP effect. (b) Treatment of 2 mg·L−1 of NPS did not alter morphological features. NPs (6 mg·L−1) exposed nauplii had altered eyeball form (c), lost eye pigment, and had fading eyes, whereas the typical eye is rounded and black (control). (d) A. nauplii was occasionally observed using a stereomicroscope (10 mg·L−1) (Labomed at 40×). Note: The yellow arrow indicates no accumulation of NPs, and the red arrow indicates the accumulation of NPs in A. nauplii’s intestine.
4 Discussion
In recent decades, the biosynthesis of AgNPs from phytoextracts has gained prominence owing to the potent antibacterial effect of zerovalent silver and the simple reduction of silver(i) ions [44]. The development of an active, environmentally friendly, and biocompatible process for synthesizing metal NPs is an attractive and well-defined research area. The aqueous extract of L. inermis contains phytochemicals that lead to the production of Ag–Cu bimetallic NPs. The color of the solution changed from light brown to dark yellow when L. inermis extract was added to the combination of Ag and Cu solution, providing the first indication of NP production. Figure 12 depicts the green synthesis of Ag–Cu bimetallic NPs. The reduction of Ag+ and Cu2+ occurs in a one-pot procedure, employing phytochemicals found in L. inermis leaf extract as reducing and stabilizing/capping molecules. As a result, during the one-pot reduction of two metal ions, Ag ions were first reduced by reducing botanical compounds, such as hennosides, coumarins, and isoplumbagin from an aqueous extract of leaves from L. inermis, and then Cu2+ ions were reduced on the surface of Ag to correspond with their potential deposition. The color change from brown to dark yellow confirms the production of Ag–Cu NPs. Similarly, Al-Haddad et al. [45] also reported on the production of Ag–Cu NPs using Phoenix dactylifera, which exhibits UV spectrum maximum at 295 nm. The UV spectrum of Ag–Cu NPs fabricated using L. inermis leaf extract was noted at 395 nm, previously reported by Al-Haddad et al. [45]. Synthesized biogenic silver nanoparticles’ surface plasmon resonance (SPR) noticed a peak with a 420 nm center that was connected to the absorbance of AgNPs [46]. The fabrication of Ag–Cu NPs using L. inermis leaf extract was analyzed by XRD. The XRD evaluations of synthesized Ag–Cu NPs show five strongest peak values at (32.12°), (38°), (44°), (64.41°), and (77.30°), which corresponds to the IC. Sagar et al. [47] found that the green-produced AgNPs from Saussurea obvallata had peak values in the XRD data of 38.49°, 44.62°, 64.85°, and 77.68°; these values corresponded to the crystalline planes of the FCC framework of AgNPs (111), (220), and (311), respectively. The crystallinity and transparency of the manufactured NPs were confirmed by the sharp peaks and removal of ambiguous peaks. The diffraction peak of the fabricated Ag–Cu NPs is broadened, whereas the peak of synthesis Ag–Cu NPs is comparatively sharp. The XRD pattern crystalline structure of NPs was demonstrated in a study conducted by Hosny et al. [29] on the Atriplex halimus Ag–Cu/biochar nanocomposite. Likewise, Yang et al. [36] studied the correlation between XRD peaks broadening and the size reduction green fabrication of Ag–Cu NPs using the medicinal plant Lucas aspera. Similarly, Dhir et al. [48] reported the XRD pattern of AgNPs produced by Amomum subulatum, exhibiting peaks corresponding to (111), (200), (220), and (311) crystal planes noticed at 2θ values 38.19°, 44.35°, 64.51°, and 77.39°.

Mortality of A. salina exposed to various amounts of fabricated bimetallic Ag–Cu NPs (2, 4, 6, 8, and 10 mg·L−1). Different lowercase letters in the same column denote statistically significant differences (p < 0.05) in the findings.
The FTIR analysis of nanomaterials showed the relation between the metal and bioactive substances present in the fabricated Ag–Cu NPs. The existence of NPs was proved by the presence of crucial functional groups, such as alcohol, alkanes, amides, aliphatic, methyl, and halides. The development of the peaks is assigned to interactions between C═O (C–O) groups and NPs, indicating that C═O and C–O groups are the anchoring ligands of the NPs with a strong affinity for coordination [49]. The existence of functional groups, viz. 3,234 cm−1, which can be assigned to phenolic functions, indicates the presence of O–H bonds. When Eltaweil et al. [50] studied the C. ambrosioides synthesized Ag@biochar, a spectral band for the O−H stretching vibration was detected at 3,274 cm−1, which they attributed to the presence of phytoconstituents containing OH functional groups, such as flavonoids, tannins, with alkaloids. Similarly, Velidandi et al. [51] stated that the green fabrications of novel Ag–Cu and Ag–Zn bimetallic NPs from Annona muricata showed the presence of functional groups aromatics and carboxylic acids. Ag–Cu NPs attached molecules appear to have both bound and free nitro groups, as shown by the peaks at 1,724 cm−1, which are carboxylic acids from phenols. For the fabrication of copper nanoparticles (Cu NPs), the presence of coumarins was determined in produced NPs and the aqueous extracts of Hippophae rhamnoides L. Comparable outcomes were also reported in the literature [52,53]. All those functional groups were involved in the potential reduction of Ag–Cu and the steadying of the produced Ag–Cu NPs. Similar findings demonstrated that the protein found in Balanites aegyptiaca functions as an agent of reduction and stabilizing agent for the CuO NPs and indicated that common functional groups of biologic molecules (such as phenols, carbonyls, and aliphatic amines) from the stem bark extract may potentially be engaged in the bio-conversion of copper ions to CuO NPs [54]. EDX of the synthesized product provides distinct elemental signals of Ag–Cu. In the present study, the element signal includes C and O. Similarly, Gopinath et al. [55] suggested that the other elements signals containing C and O are assured to the external towards Ag–Cu NPs. The EDX spectrum evidenced the signal peaks of Cu at 0.9 keV. The result was correlated with the findings observed in a strong peak of Ag at 3.4 keV peak and showed the purity of the sample. It is noticeable that metallic Ag–Cu NPs are usually shown by the absorption at 3.4 keV. FESEM analysis helps to attain the size and shapes of Ag–Cu NPs. The size of the fabricated NPs has been observed with different ranges of 41.66 nm. Sallam et al. [56] have previously published results that were similar. Porous-shaped silver/zinc nanoparticles made from Persicaria salicifolia biomass have been produced by Hosny et al. [31]. Overall, the slight aggregated form was observed in fabricated Ag–Cu NPs due to the occurrence of phytochemicals, such as phenol, polysaccharides, and other reducing sugars.
Green-synthesized Ag–Cu NPs were found to be active against targeted clinically important pathogens. The diameter of the inhibition zones is fully dependent on the species of bacteria and plant NPs. Ag–Cu NPs have potential to attach to the outer membrane of bacteria due to the occurrence of hydroxyl groups [57]. The current study noticed the green fabricated Ag–Cu NPs demonstrated strong antibacterial activity against P. aeruginosa [58]. In the work of Rathi et al. [59], bio-mediated synthesis of Ag/CuO and Ag/TiO2 from Caesalpinia pulcherrima demonstrated excellent antibacterial potential by inhibiting E. coli and S. aureus. Likewise, Gopinath et al. [55] investigated the sustainable production of Ag, Au, and Ag–Au BNPs utilizing leaf extract from Gloriosa superba, which showed potent antibacterial properties against pathogens that affect humans. The precise process underlying metal nanoparticle antimicrobial action is still undetermined [60]. However, the interaction between the negatively electric bacterial membrane and the positively electric AgNPs could be connected with their ability to generate electrostatic interactions. The relationship disturbs the structure of the bacterial membrane, which results in cell destruction and a bactericidal effect. Reactive oxygen species are produced more frequently by the binding of AgNPs with the cell membrane and mesosomes, which disrupts mesosomal function and probably kills the cell. Furthermore, the antibacterial action of Ag Cu NPs has interacted with bacterial inter-cellular cell communication and its disruption of cellular metabolisms. Second, change may result from bacterium cell viability being lost. When related to Ag and Cu NPs, it has a strong synergistic potency. Likewise, Merugu et al. [61] reported the antibacterial activity against targeted pathogens by Toddy palm synthesized bimetallic Ag/Cu NPs. According to Hosny et al. [31], the Ag/ZnO@Biohar nanocomposite-derived NPs showed bactericidal function. This is believed to be the result of two processes: first, the small particles bind to protein thiol groups, triggering deactivation; second, they communicate with microbial DNA, compressing the DNA and preventing DNA replication, which leads to death.
DPPH is one of the most significant techniques to study free radical properties that have been described in recent years [40]. The antioxidant abilities of the manufactured Ag/Cu NPs were assessed using the DPPH assay. DPPH radicals are purple in organic solvents, but yellow when showing to reducing agents or hydrogen donors. At a frequency of 517 nm, such a shift can be detected. Chemicals, as well as organic molecules with healing activities, can counteract such radicals, and a reduction in color concentration at 517 nm indicates a higher neutralizing action. The NPs’ potential to scavenge both radicals improved in a concentration-dependent pattern. At the higher doses (150 µg·mL−1), the measured DPPH free radical potentiality of the phyto-fabricated Ag–Cu by L. inermis leaf extract was found to be 68.84 ± 0.56%, whereas for the ascorbic standard (reference) was found to be 97.45 ± 0.45% at the same concentration. Similarly, Nguyen et al. [62] reported on the phytosynthesis of CuO, ZnO, and CuO/ZnO nanomaterials by leaf extract from Annona glabra. These NPs demonstrated higher antioxidant capacity by neutralizing DPPH radicals. The inhibitory rate for Ag–Cu NPs derived from L. inermis leaf extract resulted at the doses of 150 µg·mL−1; however, it was 90.23 ± 0.65% compared to 65.34 ± 0.65% for water extract in the ABTS scavenging activity. Similarly, ascorbic acid had an inhibition of 99.5 ± 90.45% at the same concentration. The outcomes also indicated that aqueous extract synthesized NPs had better radical scavenging potential in the DPPH test than they had in the ABTS assay. These studies showed that this interaction demonstrates the NPs’ reducing capacity and that the antioxidant capabilities of the Ag–Cu NPs produced by the phytoextract have been maintained, maybe due to the covering of the Ag–Cu NPs [63]. Chitturi et al. [64] observed 71.56 ± 0.55% inhibition in the DPPH radical scavenging assay at 100 µg·mL−1 by bimetallic Ag–Cu synthesized using palmyra fruit. Furthermore, Sharma et al. [65] demonstrated that the phyto-derived production of Pt and Au/Pt NPs using Syzygium aromaticum extract had powerful anti-potential by reducing DPPH (IC50-27.2 µg·mL−1) and ABTS (IC50-14 µg·mL−1). The high antioxidative capacity of L. inermis biofabricated via Ag–Cu NPs may be due to the presence of phenolic chemicals on their surface. Globally, BC is the most prevalent disease that affects women. With an expected 2.3 million new cases, or 11.7% of all tumor patients worldwide in 2020, it has presently exceeded lung cancer as the most common cause of cancer rate [66]. Radiation, chemotherapy, hormone treatment, and surgery (mastectomy and lumpectomy) are all right now employed to treat BC [66]. The absence of specificity in these treatments represents a serious drawback. Cancer nanomedicine, which is a multidisciplinary field that focuses on developing and therapeutic uses of materials and technology at the nanoscale (usually up to 100 nm), has made significant advances in the development of cancer medicines over the past several decades [67].
Nanoparticle-based targeted delivery may provide biocompatibility, multifunctional encapsulation of active ingredients, decreased degradation during the bloodstream, inactive or active targeting, efficient delivery, and fewer adverse effects. The medicinal benefits of biosynthesized NPs beyond those produced chemically are higher. The Ag–Cu NPs synthesized in this study displayed a higher inhibitory effect on BC cells, especially at the dosages of 100 µg·mL−1. Pechyen et al. [68] stated the green fabrication of Au NPs exhibited cytotoxicity properties against human breast tumor cells at maximum doses of 400 µg·mL−1. Likewise, AuNPs produced from Musa paradisiaca revealed cytotoxic efficacy against human lung tumor (A549) cells at maximum doses of 100 mg·mL−1 [69]. Similar to this, synthetic AuNPs from Annona muricata showed cytotoxic impacts on Hep2 liver cancer cells while being non-toxic to Vero cells [70]. On the other hand, the AgNPs manufactured from mushrooms were active in killing MDA-MB-231 cells at a low concentration (6 mg·mL−1). The anticancer strategy of NPs comprises intracellular enzyme and protein interactions, excessive ROS formation, and failing of mitochondrial membrane potential [71]. The presence of oxidative stress nanomaterials to be harmful to tumor cells, and DNA injury and cell alteration can affect the growth of cancer cells [72].
Artemia salina is recognized as one of the utmost valuable experimental microcrustaceans suitable for aquatic eco-toxicity screening [73]. Artemia sp. are a highly appropriate, labor-intensive-minimum living food source for aquatic cultivation due to its commonly used as a beneficial and energetic food to the larvae of many marine faunas [74]. The biotoxicity of phyto-fabricated Ag–Cu NPs from L. inermis was estimated on non-target microcrustacean A. nauplii. The outcomes showed minimal toxicity to A. nauplii (two time periods of 24 and 48 h), with LC50 and LC90 values ranging from 3.58, 5.83, and 1.51, 2.59 mg·L−1. In the control group, no notable Ag–Cu NPs were observed. The overall accumulation amounts of Ag–Cu NPs increased significantly with cumulative concentration and time exposure, confirming a time- and dose-dependent accumulation that showed a deposition of NPs in higher concentration. Similarly, Velidandi et al. [51] reported that the green fabricated platinum–palladium bimetallic NPs evaluated against Artemia nauplii at 100 μg·mL−1 demonstrated 100% mortality. Additionally, Dinesh et al. [75] studied the Phyllanthus emblica fabricated of PdNPs toxicity assessment against non-target organism A. nauplii with least LC50 value is 1.25 μg·mL−1. Madhav et al. [76] investigated the synthesized CuO NP was accumulated in the gut of A. salina and showed significant toxicity also, associated changes in biochemical markers such as catalase, reduced glutathione, and glutathione-S-transferase were evident. Many studies have evidenced a close relationship between oxidative stress and all aspects of cancer [77,78], including carcinogenesis and the tumor-bearing state, asking for necessary treatment and prevention [79]. The oxidative stress can arise from endogenous origins (at the cellular level where mitochondria are involved) [80,81], as well as exogenous origins (e.g., bacterial attack) [82]. This study evidences that technology, as always, affords new solutions to the profit of nature’s resources, also in the case of a very old medicinal plant like L. inermis [83,84]. When oxidative stress exceeds the capacity of the oxidation–reduction system of the body, the multiform activity of medicinal plant extracts, renewed by nanotechnology, can be the source of novel solutions against old challenges (Figure 11).

Schematic illustration of the possible mechanism of the green synthesis process of Ag–Cu BNPs.
5 Conclusions
Plant-based materials often exhibit advantageous properties in terms of both pest control [85,86] and medicinal applications [87]. Our method involves an environmentally friendly and cost-effective approach to synthesizing BNPs (Ag–Cu) using phytofabrication derived from L. inermis leaves, all accomplished in a single step. The leaves’ secondary metabolites, comprising phenolics, flavonoids, and tannins, act as surface-active ingredients, ensuring stability in the BNPs. Flavonoids and phenols play a role in reducing metal ions to form Ag–Cu NPs. Initial qualitative phytochemical analysis of L. inermis leaf extract revealed abundant phenols, tannins, and flavonoids. The production of nanocrystals was confirmed through spectroscopic and surface morphological methods. UV–Vis spectrophotometry showcased an SPR band at λ max 455 nm of Ag–Cu NPs. SEM images exhibited various shapes of NPs, including elongated, truncated, capsule, cubical shapes, and some aggregates. TEM and SEM images showcased spherical NPs within a size range of 20–43 nm. Moreover, the synthesized L. inermis Ag–Cu NPs displayed notable antibacterial activity, exhibiting significant growth inhibition zones against pathogenic bacteria such as P. aeruginosa (22 mm) and E. coli (19 mm) at the highest concentration. They also demonstrated remarkable antioxidant activity as DPPH radical scavengers, with the highest percentage of inhibition recorded at a concentration of 100 µg·mL−1 Ag–Cu NPs. However, acute exposure of A. nauplii to varying amounts of synthesized Ag–Cu NPs mediated by L. inermis resulted in significant behavioral changes, notable deaths, or oxidative stress within 24 h of contact. Prolonged exposure to NPs for 48 h induced oxidative stress but had minimal mortality effects.
Overall, this study underscores the potential of L. inermis-derived Ag–Cu NPs in various applications, emphasizing the need for balanced consideration of their beneficial properties alongside a thorough evaluation of their environmental and biological impacts for responsible and sustainable utilization. Further investigations into their safety profiles and long-term effects will contribute to their safe and effective implementation in diverse fields.
Acknowledgements
The authors express their sincere appreciation to the Researchers Supporting Project Number (RSP2024R48), King Saud University, Riyadh, Saudi Arabia. The Periyar University researchers are grateful to DST-FIST (SR/FIST/LSI-673/2016) for the Department of Biotechnology’s instrumentation facilities. We acknowledge the work of the Saveetha Dental College and the Saveetha Institute of Medical and Technical Sciences (SIMATS) in completing the cytotoxicity and antioxidant properties.
-
Funding information: The research was funded by Project Number (RSP2024R48) King Saud University, Riyadh, Saudi Arabia.
-
Author contributions: Chinnasamy Ragavendran – conceptualization, methodology, software, investigation; Chinnaperumal Kamaraj – software, investigation; Devarajan Natarajan – Conceptualization, methodology, formal analysis, investigation; Khalid A. Al-Ghanim – resources, writing -review and editing; Mohan Magesh – validation, formal analysis; Marcello Nicoletti – software, validation, writing-review, and editing; Marimuthu Govindarajan – software, validation, writing-review, and editing. All authors have read and agreed to the published version of the manuscript.
-
Conflict of interest: Authors state no conflict of interest.
-
Data availability statement: The datasets generated during and/or analyzed during the current study are available from the corresponding author on reasonable request.
References
[1] Khorsandi Z, Hajipour AR, Sarfjoo MR, Varma RS. Cobalt nanoparticle adorned on boron- and nitrogen-doped 2D-carbon material for Sonogashira cross-coupling reactions: Greener and efficient synthesis of anti-cancer drug, Ponatinib. Mol Catal. 2022;532:112701. 10.1016/j.mcat.2022.112701.Search in Google Scholar
[2] Ishwarya R, Vaseeharan B, Subbaiah S, Nazar AK, Govindarajan M, Alharbi NS, et al. Sargassum wightii-synthesized ZnO nanoparticles–from antibacterial and insecticidal activity to immunostimulatory effects on the green tiger shrimp Penaeus semisulcatus. J Photochem Photobiol B Biol. 2018;183:318–30. 10.1016/j.jphotobiol.2018.04.049.Search in Google Scholar PubMed
[3] Mohammadzadeh P, Ardestani MS, Mortazavi‐Derazkola S, Bitarafan‐Rajabi A, Ghoreishi SM. PEG‐Citrate dendrimer second generation: is this a good carrier for imaging agents In Vitro and In Vivo? IET Nanobiotechnol. 2019;13:560–4. 10.1049/iet-nbt.2018.5360.Search in Google Scholar PubMed PubMed Central
[4] Khatami M, Sharifi I, Nobre MAL, Zafarnia N, Aflatoonian MR. Waste-grass-mediated green synthesis of silver nanoparticles and evaluation of their anticancer, antifungal and antibacterial activity. Green Chem Lett Rev. 2018;11:125–34. 10.1080/17518253.2018.1444797.Search in Google Scholar
[5] Karthika V, Kaleeswarran P, Gopinath K, Arumugam A, Govindarajan M, Alharbi NS, et al. Biocompatible properties of nano-drug carriers using TiO2-Au embedded on multiwall carbon nanotubes for targeted drug delivery. Mater Sci Eng C. 2018;90:589–601. 10.1016/j.msec.2018.04.094.Search in Google Scholar PubMed
[6] Kaushik M, Moores A. Review: Nanocelluloses as versatile supports for metal nanoparticles and their applications in catalysis. Green Chem. 2016;18:622–37. 10.1039/C5GC02500A.Search in Google Scholar
[7] Shabbir Awan S, Taj Khan R, Mehmood A, Hafeez M, Rizwan Abass S, Nazir M, et al. Ailanthus altissima leaf extract mediated green production of zinc oxide (ZnO) nanoparticles for antibacterial and antioxidant activity. Saudi J Biol Sci. 2023;30:103487. 10.1016/j.sjbs.2022.103487.Search in Google Scholar PubMed PubMed Central
[8] Surmenev RA, Orlova T, Chernozem RV, Ivanova AA, Bartasyte A, Mathur S, et al. Hybrid lead-free polymer-based nanocomposites with improved piezoelectric response for biomedical energy-harvesting applications: A review. Nano Energy. 2019;62:475–506. 10.1016/j.nanoen.2019.04.090.Search in Google Scholar
[9] Beyene HD, Werkneh AA, Bezabh HK, Ambaye TG. Synthesis paradigm and applications of silver nanoparticles (AgNPs), a review. Sustain Mater Technol. 2017;13:18–23. 10.1016/j.susmat.2017.08.001.Search in Google Scholar
[10] Boateng J, Catanzano O. Silver and silver nanoparticle‐based antimicrobial dressings. In Therapeutic dressings and wound healing applications. Hoboken, NJ, USA: John Wiley and Sons; 2020. p. 157–84. 10.1002/9781119433316.ch8.Search in Google Scholar
[11] Kushwaha A, Goswami L, Kim BS. Nanomaterial-based therapy for wound healing. Nanomaterials. 2022;12:618. 10.3390/nano12040618.Search in Google Scholar PubMed PubMed Central
[12] Zhang Z, Liu G, Li X, Zhang S, Lü X, Wang Y. Design and synthesis of fluorescent nanocelluloses for sensing and bioimaging applications. Chempluschem. 2020;85:487–502. 10.1002/cplu.201900746.Search in Google Scholar PubMed
[13] Rana A, Chaudhary AK, Saini S, Srivastava R, Kumar M, Sharma SN. Ultrafast transient absorption spectroscopic (UFTAS) and antibacterial efficacy studies of phytofabricated silver nanoparticles using Ocimum sanctum leaf extract. Inorg Chem Commun. 2023;147:110233. 10.1016/j.inoche.2022.110233.Search in Google Scholar
[14] Kusumaningsih T, Prasetyo WE, Istiqomah A, Firdaus M, Wibowo FR. Sustainable synthesis of silver nanoparticles with enhanced anticancer, antibacterial, and antioxidant properties mediated by dimeric 2,4-diacetyl phloroglucinol: Experimental and computational insights. Surf Interfaces. 2023;36:102545. 10.1016/j.surfin.2022.102545.Search in Google Scholar
[15] Bhattacharjee S, Ghosh C, Sen A, Lala M. Characterization of Firmiana colorata (Roxb.) R. Br. leaf extract and its silver nanoparticles reveal their antioxidative, anti-microbial, and anti-inflammatory properties. Int Nano Lett. 2023;11:1–3. 10.1007/s40089-023-00392-6.Search in Google Scholar PubMed PubMed Central
[16] Fareed N, Nisa S, Bibi Y, Fareed A, Ahmed W, Sabir M, et al. Green synthesized silver nanoparticles using carrot extract exhibited strong antibacterial activity against multidrug resistant bacteria. J King Saud Univ – Sci. 2023;35:102477. 10.1016/j.jksus.2022.102477.Search in Google Scholar
[17] Al-Radadi NS, Abu-Dief AM. Silver nanoparticles (AgNPs) as a metal nano-therapy: possible mechanisms of antiviral action against COVID-19. Inorg Nano-Met Chem. 2022;52:1–19. 10.1080/24701556.2022.2068585.Search in Google Scholar
[18] Gondwal M, Sharma N, Joshi Nee Pant G, Pratap Gautam B, Singh S, Tumba K, et al. Bioactivity and catalytic reduction of aryl nitro‐compounds by biosynthesized silver nanoparticles using Skimmia anquetilia. Chem Sel. 2023;8:1–16. 10.1002/slct.202203782.Search in Google Scholar
[19] Ankudze B, Neglo D, Harley BK. Antimicrobial and biofilm formation inhibition properties of biogenic silver nanoparticles synthesised using tuber extract of Cyperus esculentus. Bionanoscience. 2023;13:103–13. 10.1007/s12668-023-01061-w.Search in Google Scholar
[20] Sharif MS, Hameed H, Waheed A, Tariq M, Afreen A, Kamal A, et al. Biofabrication of Fe3O4 nanoparticles from Spirogyra hyalina and Ajuga bracteosa and their antibacterial applications. Molecules. 2023;28:3403. 10.3390/molecules28083403.Search in Google Scholar PubMed PubMed Central
[21] Sena S, Ochatt SJ, Kumar V. Application of green synthesized nanoparticles in medicinal plant research: Revisiting an emerging eco-friendly approach. Plant Cell, Tissue Organ Cult. 2023;155:345–84. 10.1007/s11240-023-02613-4.Search in Google Scholar
[22] Alshameri AW, Owais M, Altaf I, Farheen S. Rumex nervosus mediated green synthesis of silver nanoparticles and evaluation of its in vitro antibacterial, and cytotoxic activity. OpenNano. 2022;8:100084. 10.1016/j.onano.2022.100084.Search in Google Scholar
[23] Singh H, Desimone MF, Pandya S, Jasani S, George N, Adnan M, et al. Revisiting the green synthesis of nanoparticles: Uncovering influences of plant extracts as reducing agents for enhanced synthesis efficiency and its biomedical applications. Int J Nanomed. 2023;18:4727–50. 10.2147/IJN.S419369.Search in Google Scholar PubMed PubMed Central
[24] Gour A, Jain NK. Advances in green synthesis of nanoparticles. Artif Cells Nanomed, Biotechnol. 2019;47:844–51. 10.1080/21691401.2019.1577878.Search in Google Scholar PubMed
[25] Shanmuganathan R, Karuppusamy I, Saravanan M, Muthukumar H, Ponnuchamy K, Ramkumar VS, et al. Synthesis of silver nanoparticles and their biomedical applications-a comprehensive review. Curr Pharm Des. 2019;25:2650–60. 10.2174/1381612825666190708185506.Search in Google Scholar PubMed
[26] Minal SP, Prakash S. Laboratory analysis of Au–Pd bimetallic nanoparticles synthesized with Citrus limon leaf extract and its efficacy on mosquito larvae and non-target organisms. Sci Rep. 2020;10:21610. 10.1038/s41598-020-78662-y.Search in Google Scholar PubMed PubMed Central
[27] Rezazadeh NH, Buazar F, Matroodi S. Synergistic effects of combinatorial chitosan and polyphenol biomolecules on enhanced antibacterial activity of biofunctionalized silver nanoparticles. Sci Rep. 2020;10:19615. 10.1038/s41598-020-76726-7.Search in Google Scholar PubMed PubMed Central
[28] Nejad ST, Rahimi R, Rabbani M, Rostamnia S. Facile photosynthesis of novel porphyrin-derived nanocomposites containing Ag, Ag/Au, and Ag/Cu for photobactericidal study. Sci Rep. 2023;13:8580. 10.1038/s41598-023-34745-0.Search in Google Scholar PubMed PubMed Central
[29] Hosny M, Fawzy M, Eltaweil AS. Phytofabrication of bimetallic silver-copper/biochar nanocomposite for environmental and medical applications. J Environ Manage. 2022;316:115238. 10.1016/j.jenvman.2022.115238.Search in Google Scholar PubMed
[30] Shi W, Liu C, Li M, Lin X, Guo F, Shi J. Fabrication of ternary Ag3PO4/Co3 (PO4)2/g-C3N4 heterostructure with following Type II and Z-Scheme dual pathways for enhanced visible-light photocatalytic activity. J Hazard Mater. 2020;389:121907. 10.1016/j.jhazmat.2019.121907.Search in Google Scholar PubMed
[31] Hosny M, Fawzy M, Eltaweil AS. Green synthesis of bimetallic Ag/ZnO@ Biohar nanocomposite for photocatalytic degradation of tetracycline, antibacterial and antioxidant activities. Sci Rep. 2022;12:7316. 10.1038/s41598-022-11014-0.Search in Google Scholar PubMed PubMed Central
[32] Badoni Semwal R, Semwal DK, Combrinck S, Cartwright-Jones C, Viljoen A. Lawsonia inermis L. (henna): Ethnobotanical, phytochemical and pharmacological aspects. J Ethnopharmacol. 2014;155:80–103. 10.1016/j.jep.2014.05.042.Search in Google Scholar PubMed
[33] Dalal R, Singh S, Sangwan S, Moond M, Beniwal R. Biochemical and Molecular Mechanism of Plant-mediated Synthesis of Silver Nanoparticles – A Review. Mini Rev Org Chem. 2022;19:939–54. 10.2174/1570193X19666220127124622.Search in Google Scholar
[34] Rajabi S, Ramazani A, Hamidi M, Naji T. Artemia salina as a model organism in toxicity assessment of nanoparticles. DARU J Pharm Sci. 2015;23:20. 10.1186/s40199-015-0105-x.Search in Google Scholar PubMed PubMed Central
[35] Balaei-Kahnamoei M, Saeedi M, Rastegari A, Shams Ardekani MR, Akbarzadeh T, Khanavi M. Phytochemical analysis and evaluation of biological activity of lawsonia inermis seeds related to Alzheimer’s Disease. Evid Based Complementary Altern Med. 2021;2021:1–10. 10.1155/2021/5965061.Search in Google Scholar PubMed PubMed Central
[36] Yang H, Zhang X, Velu P, Liu X, Vijayalakshmi A. Enhanced green mediated synthesis of optimized Ag–Cu bimetallic nanoparticles using Leucas aspera and its application in Anti-cancer activity against alveolar cancer. Mater Lett. 2313;22:131645. 10.1016/j.matlet.2021.131645.Search in Google Scholar
[37] Sopoušek J, Pinkas J, Brož P, Buršík J, Vykoukal V, Škoda D, et al. Ag–Cu colloid synthesis: Bimetallic nanoparticle characterisation and thermal treatment. J Nanomater. 2014;2014:1–13. 10.1155/2014/638964.Search in Google Scholar
[38] Niloy MS, Hossain MM, Takikawa M, Shakil MS, Polash SA, Mahmud KM, et al. Synthesis of biogenic silver nanoparticles using Caesalpinia digyna and investigation of their antimicrobial activity and in vivo biocompatibility. ACS Appl Bio Mater. 2020;3:7722–33. 10.1021/acsabm.0c00926.Search in Google Scholar PubMed
[39] Rudrappa M, Rudayni HA, Assiri RA, Bepari A, Basavarajappa DS, Nagaraja SK, et al. Plumeria alba-mediated green synthesis of silver nanoparticles exhibits antimicrobial effect and anti-oncogenic activity against glioblastoma U118 MG cancer cell line. Nanomaterials. 2022;12:493. 10.3390/nano12030493.Search in Google Scholar PubMed PubMed Central
[40] Kiani Z, Aramjoo H, Chamani E, Siami-Aliabad M, Mortazavi-Derazkola S. In vitro cytotoxicity against K562 tumor cell line, antibacterial, antioxidant, antifungal and catalytic activities of biosynthesized silver nanoparticles using Sophora pachycarpa extract. Arab J Chem. 2022;15:103677. 10.1016/j.arabjc.2021.103677.Search in Google Scholar
[41] Chinnasamy R, Kamaraj C, Venkatesan M, Jogikalmat K, Cherian T, Willie P, et al. Eco-friendly synthesis of Ag-NPs using Endostemon viscosus (Lamiaceae): Antibacterial, antioxidant, larvicidal, photocatalytic dye degradation activity and toxicity in zebrafish embryos. Environ Res. 2023;218:114946. 10.1016/j.envres.2022.114946.Search in Google Scholar PubMed
[42] Krishnaraj C, Muthukumaran P, Ramachandran R, Balakumaran MD, Kalaichelvan PT. Acalypha indica Linn: Biogenic synthesis of silver and gold nanoparticles and their cytotoxic effects against MDA-MB-231, human breast cancer cells. Biotechnol Rep. 2014;4:42–9. 10.1016/j.btre.2014.08.002.Search in Google Scholar PubMed PubMed Central
[43] Ates M, Daniels J, Arslan Z, Farah IO. Effects of aqueous suspensions of titanium dioxide nanoparticles on Artemia salina: Assessment of nanoparticle aggregation, accumulation, and toxicity. Environ Monit Assess. 2013;185:3339–48. 10.1007/s10661-012-2794-7.Search in Google Scholar PubMed PubMed Central
[44] Hashemi Z, Mizwari ZM, Mohammadi-Aghdam S, Mortazavi-Derazkola S, Ali Ebrahimzadeh M. Sustainable green synthesis of silver nanoparticles using Sambucus ebulus phenolic extract (AgNPs@SEE): Optimization and assessment of photocatalytic degradation of methyl orange and their in vitro antibacterial and anticancer activity. Arab J Chem. 2022;15:103525. 10.1016/j.arabjc.2021.103525.Search in Google Scholar
[45] Al-Haddad J, Alzaabi F, Pal P, Rambabu K, Banat F. Green synthesis of bimetallic copper–silver nanoparticles and their application in catalytic and antibacterial activities. Clean Technol Environ Policy. 2020;22:269–77. 10.1007/s10098-019-01765-2.Search in Google Scholar
[46] Shirzadi-Ahodashti M, Mizwari ZM, Hashemi Z, Rajabalipour S, Ghoreishi SM, Mortazavi-Derazkola S, et al. Discovery of high antibacterial and catalytic activities of biosynthesized silver nanoparticles using C. fruticosus (CF-AgNPs) against multi-drug resistant clinical strains and hazardous pollutants. Environ Technol Innov. 2021;23:101607. 10.1016/j.eti.2021.101607.Search in Google Scholar
[47] Sagar PV, Ramadevi D, Basavaiah K, Botsa SM. Green synthesis of silver nanoparticles using aqueous leaf extract of Saussurea obvallata for efficient catalytic reduction of nitrophenol, antioxidant, and antibacterial activity. Water Sci Eng. 2023;1–11. 10.1016/j.wse.2023.09.004.Search in Google Scholar
[48] Dhir S, Dutt R, Singh RP, Chauhan M, Virmani T, Kumar G, et al. Amomum Subulatum fruit extract mediated green synthesis of silver and copper oxide nanoparticles: synthesis, characterization, antibacterial and anticancer activities. Processes. 2023;11:2698. 10.3390/pr11092698.Search in Google Scholar
[49] Zhan G, Huang J, Du M, Abdul-Rauf I, Ma Y, Li Q. Green synthesis of Au–Pd bimetallic nanoparticles: Single-step bioreduction method with plant extract. Mater Lett. 2011;65:2989–91. 10.1016/j.matlet.2011.06.079.Search in Google Scholar
[50] Eltaweil AS, Abdelfatah AM, Hosny M, Fawzy M. Novel biogenic synthesis of a Ag@ Biochar nanocomposite as an antimicrobial agent and photocatalyst for methylene blue degradation. ACS Omega. 2022;7:8046–59. 10.1021/acsomega.1c07209.Search in Google Scholar PubMed PubMed Central
[51] Velidandi A, Sarvepalli M, Pabbathi NPP, Baadhe RR. Biogenic synthesis of novel platinum–palladium bimetallic nanoparticles from aqueous Annona muricata leaf extract for catalytic activity. 3 Biotech. 2021;11:385. 10.1007/s13205-021-02935-0.Search in Google Scholar PubMed PubMed Central
[52] Dadhwal P, Dhingra HK, Dwivedi V, Alarifi S, Kalasariya H, Yadav VK, et al. Hippophae rhamnoides L.(sea buckthorn) mediated green synthesis of copper nanoparticles and their application in anticancer activity. Front Mol Biosci. 2023;10:1246728. 10.3389/fmolb.2023.1246728.Search in Google Scholar PubMed PubMed Central
[53] Sarwar N, Humayoun UB, Kumar M, Zaidi SF, Yoo JH, Ali N, et al. Citric acid mediated green synthesis of copper nanoparticles using cinnamon bark extract and its multifaceted applications. J Clean Prod. 2021;292:125974. 10.1016/j.jclepro.2021.125974.Search in Google Scholar
[54] Teklu B, Kadiri SK, Vidavalur S. Green synthesis of copper oxide nanoparticles using Balanites aegyptiaca stem bark extract and investigation of antibacterial activity. Results Chem. 2023;6:101152. 10.1016/j.rechem.2023.101152.Search in Google Scholar
[55] Gopinath K, Kumaraguru S, Bhakyaraj K, Mohan S, Venkatesh KS, Esakkirajan M, et al. Green synthesis of silver, gold and silver/gold bimetallic nanoparticles using the Gloriosa superba leaf extract and their antibacterial and antibiofilm activities. Microb Pathog. 2016;101:1–11. 10.1016/j.micpath.2016.10.011.Search in Google Scholar PubMed
[56] Sallam SA, El-Subruiti GM, Eltaweil AS. Facile synthesis of Ag–γ-Fe2O3 superior nanocomposite for catalytic reduction of nitroaromatic compounds and catalytic degradation of methyl orange. Catal Lett. 2018;148:3701–14. 10.1007/s10562-018-2569-z.Search in Google Scholar
[57] Crisan MC, Teodora M, Lucian M. Copper nanoparticles: Synthesis and characterization, physiology, toxicity and antimicrobial applications. Appl Sci. 2021;12:141. 10.3390/app12010141.Search in Google Scholar
[58] Jang J, Lee JM, Oh SB, Choi Y, Jung HS, Choi J. Development of Antibiofilm Nanocomposites: Ag/Cu Bimetallic Nanoparticles Synthesized on the Surface of Graphene Oxide Nanosheets. ACS Appl Mater Interfaces. 2020;12:35826–34. 10.1021/acsami.0c06054.Search in Google Scholar PubMed
[59] Rathi VH, Jeice AR, Jayakumar K. Green synthesis of Ag/CuO and Ag/TiO2 nanoparticles for enhanced photocatalytic dye degradation, antibacterial, and antifungal properties. Appl Surf Sci Adv. 2023;18:100476. 10.1016/j.apsadv.2023.100476.Search in Google Scholar
[60] Alshameri AW, Owais M. Antibacterial and cytotoxic potency of the plant-mediated synthesis of metallic nanoparticles Ag NPs and ZnO NPs: A review. OpenNano. 2022;8:100077. 10.1016/j.onano.2022.100077.Search in Google Scholar
[61] Merugu R, Gothalwal R, Kaushik Deshpande P, De Mandal S, Padala G, Latha Chitturi K. Synthesis of Ag/Cu and Cu/Zn bimetallic nanoparticles using toddy palm: Investigations of their antitumor, antioxidant and antibacterial activities. Mater Today Proc. 2021;44:99–105. 10.1016/j.matpr.2020.08.027.Search in Google Scholar
[62] Nguyen TT, Nguyen YN, Tran XT, Nguyen TT, Van Tran T. Green synthesis of CuO, ZnO and CuO/ZnO nanoparticles using Annona glabra leaf Extr antioxidant, Antibact photocatalytic activities. J Environ Chem Eng. 2023;11:111003. 10.1016/j.jece.2023.111003.Search in Google Scholar
[63] Mittal AK, Bhaumik J, Kumar S, Banerjee UC. Biosynthesis of silver nanoparticles: Elucidation of prospective mechanism and therapeutic potential. J Colloid Interface Sci. 2014;415:39–47. 10.1016/j.jcis.2013.10.018.Search in Google Scholar PubMed
[64] Chitturi KL, Garimella S, Marapaka AK, Kudle KR, Merugu R. Single pot green synthesis, characterization, antitumor antibacterial, antioxidant activity of bimetallic silver and copper nanoparticles using fruit pulp of palmyra fruit. J Bionanosci. 2018;12:284–9. 10.1166/jbns.2018.1520.Search in Google Scholar
[65] Sharma C, Ansari S, Ansari MS, Satsangee SP. Phyto-mediated synthesis of Pt and Au/Pt bimetallic nanoparticles using Syzygium aromaticum bud-extract: Study of their catalytic, antibacterial, and antioxidant activities. J Ind Eng Chem. 2022;111:499–508. 10.1016/j.jiec.2022.04.031.Search in Google Scholar
[66] Mehrotra R, Yadav K. Breast cancer in India: Present scenario and the challenges ahead. World J Clin Oncol. 2022;13:209–18. 10.5306/wjco.v13.i3.209.Search in Google Scholar PubMed PubMed Central
[67] Tang X, Loc WS, Dong C, Matters GL, Butler PJ, Kester M, et al. The use of nanoparticulates to treat breast cancer. Nanomedicine. 2017;12:2367–88. 10.2217/nnm-2017-0202.Search in Google Scholar PubMed PubMed Central
[68] Pechyen C, Ponsanti K, Tangnorawich B, Ngernyuang N. Biogenic synthesis of gold nanoparticles mediated by Spondias dulcis (Anacardiaceae) peel extract and its cytotoxic activity in human breast cancer cell. Toxicol Rep. 2022;9:1092–8. 10.1016/j.toxrep.2022.04.031.Search in Google Scholar PubMed PubMed Central
[69] Vijayakumar S, Vaseeharan B, Malaikozhundan B, Gopi N, Ekambaram P, Pachaiappan R, et al. Therapeutic effects of gold nanoparticles synthesized using Musa paradisiaca peel extract against multiple antibiotic resistant Enterococcus faecalis biofilms and human lung cancer cells (A549). Microb Pathog. 2017;102:173–83. 10.1016/j.micpath.2016.11.029.Search in Google Scholar PubMed
[70] Priya K, Iyer MRPR. Antiproliferative effects on tumor cells of the synthesized gold nanoparticles against Hep2 liver cancer cell line. Egypt Liver J. 2020;10:15. 10.1186/s43066-020-0017-4.Search in Google Scholar
[71] Sabaratnam V, Gurunathan S, Raman J, Abd Malek SN, John P. Green synthesis of silver nanoparticles using Ganoderma neo-japonicum Imazeki: a potential cytotoxic agent against breast cancer cells. Int J Nanomed. 2013;8:4399. 10.2147/IJN.S51881.Search in Google Scholar PubMed PubMed Central
[72] Wei A, Pan L, Huang W. Recent progress in the ZnO nanostructure-based sensors. Mater Sci Eng B. 2011;176:1409–21. 10.1016/j.mseb.2011.09.005.Search in Google Scholar
[73] Velidandi A, Pabbathi NPP, Dahariya S, Kagithoju S, Baadhe RR. Bio-fabrication of silver–silver chloride nanoparticles using Annona muricata leaf extract: characterization, biological, dye degradation and eco-toxicity studies. Int J Environ Sci Technol. 2022;19:6555–72. 10.1007/s13762-021-03461-5.Search in Google Scholar
[74] Arulvasu C, Jennifer SM, Prabhu D, Chandhirasekar D. Toxicity Effect of Silver Nanoparticles in Brine Shrimp Artemia. Sci World J. 2014;2014:1–10. 10.1155/2014/256919.Search in Google Scholar PubMed PubMed Central
[75] Dinesh M, Roopan SM, Selvaraj CI, Arunachalam P. Phyllanthus emblica seed extract mediated synthesis of PdNPs against antibacterial, heamolytic and cytotoxic studies. J Photochem Photobiol B Biol. 2017;167:64–71. 10.1016/j.jphotobiol.2016.12.012.Search in Google Scholar PubMed
[76] Madhav MR, David SEM, Kumar RSS, Swathy JS, Bhuvaneshwari M, Mukherjee A, et al. Toxicity and accumulation of Copper oxide (CuO) nanoparticles in different life stages of Artemia salina. Environ Toxicol Pharmacol. 2017;52:227–38. 10.1016/j.etap.2017.03.013.Search in Google Scholar PubMed
[77] Sanati M, Afshari AR, Kesharwani P, Sukhorukov VN, Sahebkar A. Recent trends in the application of nanoparticles in cancer therapy: The involvement of oxidative stress. J Control Rel. 2022;348:287–304. 10.1016/j.jconrel.2022.05.035.Search in Google Scholar PubMed
[78] Taucher E, Mykoliuk I, Fediuk M, Smolle-Juettner FM. Autophagy, Oxidative Stress and Cancer Development. Cancers (Basel). 2022;14:1637. 10.3390/cancers14071637.Search in Google Scholar PubMed PubMed Central
[79] Lu L, Dong J, Liu Y, Qian Y, Zhang G, Zhou W, et al. New insights into natural products that target the gut microbiota: Effects on the prevention and treatment of colorectal cancer. Front Pharmacol. 2022;13:964793. 10.3389/fphar.2022.964793.Search in Google Scholar PubMed PubMed Central
[80] Kuo CL, Ponneri Babuharisankar A, Lin YC, Lien HW, Lo YK, Chou HY, et al. Mitochondrial oxidative stress in the tumor microenvironment and cancer immunoescape: foe or friend? J Biomed Sci. 2022;29:74. 10.1186/s12929-022-00859-2.Search in Google Scholar PubMed PubMed Central
[81] Maldonado E, Morales-Pison S, Urbina F, Solari A. Aging Hallmarks and the Role of Oxidative Stress. Antioxidants. 2023;12:651. 10.3390/antiox12030651.Search in Google Scholar PubMed PubMed Central
[82] Grochowska M, Perlejewski K, Laskus T, Radkowski M. The Role of Gut Microbiota in Gastrointestinal Tract Cancers. Arch Immunol Ther Exp (Warsz). 2022;70:7. 10.1007/s00005-021-00641-6.Search in Google Scholar PubMed PubMed Central
[83] Mandlik DS, Mandlik SK. An Overview of Hepatocellular Carcinoma with Emphasis on Dietary Products and Herbal Remedies. Nutr Cancer. 2022;74:1549–67. 10.1080/01635581.2021.1965630.Search in Google Scholar PubMed
[84] Hassen A, Muche M, Muasya AM, Tsegay BA. Exploration of traditional plant-based medicines used for livestock ailments in northeastern Ethiopiaby. South Afr J Bot. 2022;146:230–42. 10.1016/j.sajb.2021.10.018.Search in Google Scholar
[85] Govindarajan M. Evaluation of indigenous plant extracts against the malarial vector, Anopheles stephensi (Liston)(Diptera: Culicidae). Parasitol Res. 2011;109:93–103. 10.1007/s00436-010-2224-0.Search in Google Scholar PubMed
[86] Benelli G, Govindarajan M, Rajeswary M, Vaseeharan B, Alyahya SA, Alharbi NS, et al. Insecticidal activity of camphene, zerumbone and α-humulene from Cheilocostus speciosus rhizome essential oil against the Old-World bollworm, Helicoverpa armigera. Ecotoxicol Environ Saf. 2018;148:781–6. 10.1016/j.ecoenv.2017.11.044.Search in Google Scholar PubMed
[87] Kolanjinathan K, Ganesh P, Govindarajan M. Antibacterial activity of ethanol extracts of seaweeds against fish bacterial pathogens. Eur Rev Med Pharmacol Sci. 2009;13:173–7.Search in Google Scholar
© 2024 the author(s), published by De Gruyter
This work is licensed under the Creative Commons Attribution 4.0 International License.
Articles in the same Issue
- Research Articles
- Green polymer electrolyte and activated charcoal-based supercapacitor for energy harvesting application: Electrochemical characteristics
- Research on the adsorption of Co2+ ions using halloysite clay and the ability to recover them by electrodeposition method
- Simultaneous estimation of ibuprofen, caffeine, and paracetamol in commercial products using a green reverse-phase HPTLC method
- Isolation, screening and optimization of alkaliphilic cellulolytic fungi for production of cellulase
- Functionalized gold nanoparticles coated with bacterial alginate and their antibacterial and anticancer activities
- Comparative analysis of bio-based amino acid surfactants obtained via Diels–Alder reaction of cyclic anhydrides
- Biosynthesis of silver nanoparticles on yellow phosphorus slag and its application in organic coatings
- Exploring antioxidant potential and phenolic compound extraction from Vitis vinifera L. using ultrasound-assisted extraction
- Manganese and copper-coated nickel oxide nanoparticles synthesized from Carica papaya leaf extract induce antimicrobial activity and breast cancer cell death by triggering mitochondrial caspases and p53
- Insight into heating method and Mozafari method as green processing techniques for the synthesis of micro- and nano-drug carriers
- Silicotungstic acid supported on Bi-based MOF-derived metal oxide for photodegradation of organic dyes
- Synthesis and characterization of capsaicin nanoparticles: An attempt to enhance its bioavailability and pharmacological actions
- Synthesis of Lawsonia inermis-encased silver–copper bimetallic nanoparticles with antioxidant, antibacterial, and cytotoxic activity
- Facile, polyherbal drug-mediated green synthesis of CuO nanoparticles and their potent biological applications
- Zinc oxide-manganese oxide/carboxymethyl cellulose-folic acid-sesamol hybrid nanomaterials: A molecularly targeted strategy for advanced triple-negative breast cancer therapy
- Exploring the antimicrobial potential of biogenically synthesized graphene oxide nanoparticles against targeted bacterial and fungal pathogens
- Biofabrication of silver nanoparticles using Uncaria tomentosa L.: Insight into characterization, antibacterial activities combined with antibiotics, and effect on Triticum aestivum germination
- Membrane distillation of synthetic urine for use in space structural habitat systems
- Investigation on mechanical properties of the green synthesis bamboo fiber/eggshell/coconut shell powder-based hybrid biocomposites under NaOH conditions
- Green synthesis of magnesium oxide nanoparticles using endophytic fungal strain to improve the growth, metabolic activities, yield traits, and phenolic compounds content of Nigella sativa L.
- Estimation of greenhouse gas emissions from rice and annual upland crops in Red River Delta of Vietnam using the denitrification–decomposition model
- Synthesis of humic acid with the obtaining of potassium humate based on coal waste from the Lenger deposit, Kazakhstan
- Ascorbic acid-mediated selenium nanoparticles as potential antihyperuricemic, antioxidant, anticoagulant, and thrombolytic agents
- Green synthesis of silver nanoparticles using Illicium verum extract: Optimization and characterization for biomedical applications
- Antibacterial and dynamical behaviour of silicon nanoparticles influenced sustainable waste flax fibre-reinforced epoxy composite for biomedical application
- Optimising coagulation/flocculation using response surface methodology and application of floc in biofertilisation
- Green synthesis and multifaceted characterization of iron oxide nanoparticles derived from Senna bicapsularis for enhanced in vitro and in vivo biological investigation
- Potent antibacterial nanocomposites from okra mucilage/chitosan/silver nanoparticles for multidrug-resistant Salmonella Typhimurium eradication
- Trachyspermum copticum aqueous seed extract-derived silver nanoparticles: Exploration of their structural characterization and comparative antibacterial performance against gram-positive and gram-negative bacteria
- Microwave-assisted ultrafine silver nanoparticle synthesis using Mitragyna speciosa for antimalarial applications
- Green synthesis and characterisation of spherical structure Ag/Fe2O3/TiO2 nanocomposite using acacia in the presence of neem and tulsi oils
- Green quantitative methods for linagliptin and empagliflozin in dosage forms
- Enhancement efficacy of omeprazole by conjugation with silver nanoparticles as a urease inhibitor
- Residual, sequential extraction, and ecological risk assessment of some metals in ash from municipal solid waste incineration, Vietnam
- Green synthesis of ZnO nanoparticles using the mangosteen (Garcinia mangostana L.) leaf extract: Comparative preliminary in vitro antibacterial study
- Simultaneous determination of lesinurad and febuxostat in commercial fixed-dose combinations using a greener normal-phase HPTLC method
- A greener RP-HPLC method for quaternary estimation of caffeine, paracetamol, levocetirizine, and phenylephrine acquiring AQbD with stability studies
- Optimization of biomass durian peel as a heterogeneous catalyst in biodiesel production using microwave irradiation
- Thermal treatment impact on the evolution of active phases in layered double hydroxide-based ZnCr photocatalysts: Photodegradation and antibacterial performance
- Preparation of silymarin-loaded zein polysaccharide core–shell nanostructures and evaluation of their biological potentials
- Preparation and characterization of composite-modified PA6 fiber for spectral heating and heat storage applications
- Preparation and electrocatalytic oxygen evolution of bimetallic phosphates (NiFe)2P/NF
- Rod-shaped Mo(vi) trichalcogenide–Mo(vi) oxide decorated on poly(1-H pyrrole) as a promising nanocomposite photoelectrode for green hydrogen generation from sewage water with high efficiency
- Green synthesis and studies on citrus medica leaf extract-mediated Au–ZnO nanocomposites: A sustainable approach for efficient photocatalytic degradation of rhodamine B dye in aqueous media
- Cellulosic materials for the removal of ciprofloxacin from aqueous environments
- The analytical assessment of metal contamination in industrial soils of Saudi Arabia using the inductively coupled plasma technology
- The effect of modified oily sludge on the slurry ability and combustion performance of coal water slurry
- Eggshell waste transformation to calcium chloride anhydride as food-grade additive and eggshell membranes as enzyme immobilization carrier
- Synthesis of EPAN and applications in the encapsulation of potassium humate
- Biosynthesis and characterization of silver nanoparticles from Cedrela toona leaf extracts: An exploration into their antibacterial, anticancer, and antioxidant potential
- Enhancing mechanical and rheological properties of HDPE films through annealing for eco-friendly agricultural applications
- Immobilisation of catalase purified from mushroom (Hydnum repandum) onto glutaraldehyde-activated chitosan and characterisation: Its application for the removal of hydrogen peroxide from artificial wastewater
- Sodium titanium oxide/zinc oxide (STO/ZnO) photocomposites for efficient dye degradation applications
- Effect of ex situ, eco-friendly ZnONPs incorporating green synthesised Moringa oleifera leaf extract in enhancing biochemical and molecular aspects of Vicia faba L. under salt stress
- Biosynthesis and characterization of selenium and silver nanoparticles using Trichoderma viride filtrate and their impact on Culex pipiens
- Photocatalytic degradation of organic dyes and biological potentials of biogenic zinc oxide nanoparticles synthesized using the polar extract of Cyperus scariosus R.Br. (Cyperaceae)
- Assessment of antiproliferative activity of green-synthesized nickel oxide nanoparticles against glioblastoma cells using Terminalia chebula
- Chlorine-free synthesis of phosphinic derivatives by change in the P-function
- Anticancer, antioxidant, and antimicrobial activities of nanoemulsions based on water-in-olive oil and loaded on biogenic silver nanoparticles
- Study and mechanism of formation of phosphorus production waste in Kazakhstan
- Synthesis and stabilization of anatase form of biomimetic TiO2 nanoparticles for enhancing anti-tumor potential
- Microwave-supported one-pot reaction for the synthesis of 5-alkyl/arylidene-2-(morpholin/thiomorpholin-4-yl)-1,3-thiazol-4(5H)-one derivatives over MgO solid base
- Screening the phytochemicals in Perilla leaves and phytosynthesis of bioactive silver nanoparticles for potential antioxidant and wound-healing application
- Graphene oxide/chitosan/manganese/folic acid-brucine functionalized nanocomposites show anticancer activity against liver cancer cells
- Nature of serpentinite interactions with low-concentration sulfuric acid solutions
- Multi-objective statistical optimisation utilising response surface methodology to predict engine performance using biofuels from waste plastic oil in CRDi engines
- Microwave-assisted extraction of acetosolv lignin from sugarcane bagasse and electrospinning of lignin/PEO nanofibres for carbon fibre production
- Biosynthesis, characterization, and investigation of cytotoxic activities of selenium nanoparticles utilizing Limosilactobacillus fermentum
- Highly photocatalytic materials based on the decoration of poly(O-chloroaniline) with molybdenum trichalcogenide oxide for green hydrogen generation from Red Sea water
- Highly efficient oil–water separation using superhydrophobic cellulose aerogels derived from corn straw
- Beta-cyclodextrin–Phyllanthus emblica emulsion for zinc oxide nanoparticles: Characteristics and photocatalysis
- Assessment of antimicrobial activity and methyl orange dye removal by Klebsiella pneumoniae-mediated silver nanoparticles
- Influential eradication of resistant Salmonella Typhimurium using bioactive nanocomposites from chitosan and radish seed-synthesized nanoselenium
- Antimicrobial activities and neuroprotective potential for Alzheimer’s disease of pure, Mn, Co, and Al-doped ZnO ultra-small nanoparticles
- Green synthesis of silver nanoparticles from Bauhinia variegata and their biological applications
- Synthesis and optimization of long-chain fatty acids via the oxidation of long-chain fatty alcohols
- Eminent Red Sea water hydrogen generation via a Pb(ii)-iodide/poly(1H-pyrrole) nanocomposite photocathode
- Green synthesis and effective genistein production by fungal β-glucosidase immobilized on Al2O3 nanocrystals synthesized in Cajanus cajan L. (Millsp.) leaf extracts
- Green stability-indicating RP-HPTLC technique for determining croconazole hydrochloride
- Green synthesis of La2O3–LaPO4 nanocomposites using Charybdis natator for DNA binding, cytotoxic, catalytic, and luminescence applications
- Eco-friendly drugs induce cellular changes in colistin-resistant bacteria
- Tangerine fruit peel extract mediated biogenic synthesized silver nanoparticles and their potential antimicrobial, antioxidant, and cytotoxic assessments
- Green synthesis on performance characteristics of a direct injection diesel engine using sandbox seed oil
- A highly sensitive β-AKBA-Ag-based fluorescent “turn off” chemosensor for rapid detection of abamectin in tomatoes
- Green synthesis and physical characterization of zinc oxide nanoparticles (ZnO NPs) derived from the methanol extract of Euphorbia dracunculoides Lam. (Euphorbiaceae) with enhanced biosafe applications
- Detection of morphine and data processing using surface plasmon resonance imaging sensor
- Effects of nanoparticles on the anaerobic digestion properties of sulfamethoxazole-containing chicken manure and analysis of bio-enzymes
- Bromic acid-thiourea synergistic leaching of sulfide gold ore
- Green chemistry approach to synthesize titanium dioxide nanoparticles using Fagonia Cretica extract, novel strategy for developing antimicrobial and antidiabetic therapies
- Green synthesis and effective utilization of biogenic Al2O3-nanocoupled fungal lipase in the resolution of active homochiral 2-octanol and its immobilization via aluminium oxide nanoparticles
- Eco-friendly RP-HPLC approach for simultaneously estimating the promising combination of pentoxifylline and simvastatin in therapeutic potential for breast cancer: Appraisal of greenness, whiteness, and Box–Behnken design
- Use of a humidity adsorbent derived from cockleshell waste in Thai fried fish crackers (Keropok)
- One-pot green synthesis, biological evaluation, and in silico study of pyrazole derivatives obtained from chalcones
- Bio-sorption of methylene blue and production of biofuel by brown alga Cystoseira sp. collected from Neom region, Kingdom of Saudi Arabia
- Synthesis of motexafin gadolinium: A promising radiosensitizer and imaging agent for cancer therapy
- The impact of varying sizes of silver nanoparticles on the induction of cellular damage in Klebsiella pneumoniae involving diverse mechanisms
- Microwave-assisted green synthesis, characterization, and in vitro antibacterial activity of NiO nanoparticles obtained from lemon peel extract
- Rhus microphylla-mediated biosynthesis of copper oxide nanoparticles for enhanced antibacterial and antibiofilm efficacy
- Harnessing trichalcogenide–molybdenum(vi) sulfide and molybdenum(vi) oxide within poly(1-amino-2-mercaptobenzene) frameworks as a photocathode for sustainable green hydrogen production from seawater without sacrificial agents
- Magnetically recyclable Fe3O4@SiO2 supported phosphonium ionic liquids for efficient and sustainable transformation of CO2 into oxazolidinones
- A comparative study of Fagonia arabica fabricated silver sulfide nanoparticles (Ag2S) and silver nanoparticles (AgNPs) with distinct antimicrobial, anticancer, and antioxidant properties
- Visible light photocatalytic degradation and biological activities of Aegle marmelos-mediated cerium oxide nanoparticles
- Physical intrinsic characteristics of spheroidal particles in coal gasification fine slag
- Exploring the effect of tea dust magnetic biochar on agricultural crops grown in polycyclic aromatic hydrocarbon contaminated soil
- Crosslinked chitosan-modified ultrafiltration membranes for efficient surface water treatment and enhanced anti-fouling performances
- Study on adsorption characteristics of biochars and their modified biochars for removal of organic dyes from aqueous solution
- Zein polymer nanocarrier for Ocimum basilicum var. purpurascens extract: Potential biomedical use
- Green synthesis, characterization, and in vitro and in vivo biological screening of iron oxide nanoparticles (Fe3O4) generated with hydroalcoholic extract of aerial parts of Euphorbia milii
- Novel microwave-based green approach for the synthesis of dual-loaded cyclodextrin nanosponges: Characterization, pharmacodynamics, and pharmacokinetics evaluation
- Bi2O3–BiOCl/poly-m-methyl aniline nanocomposite thin film for broad-spectrum light-sensing
- Green synthesis and characterization of CuO/ZnO nanocomposite using Musa acuminata leaf extract for cytotoxic studies on colorectal cancer cells (HCC2998)
- Review Articles
- Materials-based drug delivery approaches: Recent advances and future perspectives
- A review of thermal treatment for bamboo and its composites
- An overview of the role of nanoherbicides in tackling challenges of weed management in wheat: A novel approach
- An updated review on carbon nanomaterials: Types, synthesis, functionalization and applications, degradation and toxicity
- Special Issue: Emerging green nanomaterials for sustainable waste management and biomedical applications
- Green synthesis of silver nanoparticles using mature-pseudostem extracts of Alpinia nigra and their bioactivities
- Special Issue: New insights into nanopythotechnology: current trends and future prospects
- Green synthesis of FeO nanoparticles from coffee and its application for antibacterial, antifungal, and anti-oxidation activity
- Dye degradation activity of biogenically synthesized Cu/Fe/Ag trimetallic nanoparticles
- Special Issue: Composites and green composites
- Recent trends and advancements in the utilization of green composites and polymeric nanocarriers for enhancing food quality and sustainable processing
- Retraction
- Retraction of “Biosynthesis and characterization of silver nanoparticles from Cedrela toona leaf extracts: An exploration into their antibacterial, anticancer, and antioxidant potential”
- Retraction of “Photocatalytic degradation of organic dyes and biological potentials of biogenic zinc oxide nanoparticles synthesized using the polar extract of Cyperus scariosus R.Br. (Cyperaceae)”
- Retraction to “Green synthesis on performance characteristics of a direct injection diesel engine using sandbox seed oil”
Articles in the same Issue
- Research Articles
- Green polymer electrolyte and activated charcoal-based supercapacitor for energy harvesting application: Electrochemical characteristics
- Research on the adsorption of Co2+ ions using halloysite clay and the ability to recover them by electrodeposition method
- Simultaneous estimation of ibuprofen, caffeine, and paracetamol in commercial products using a green reverse-phase HPTLC method
- Isolation, screening and optimization of alkaliphilic cellulolytic fungi for production of cellulase
- Functionalized gold nanoparticles coated with bacterial alginate and their antibacterial and anticancer activities
- Comparative analysis of bio-based amino acid surfactants obtained via Diels–Alder reaction of cyclic anhydrides
- Biosynthesis of silver nanoparticles on yellow phosphorus slag and its application in organic coatings
- Exploring antioxidant potential and phenolic compound extraction from Vitis vinifera L. using ultrasound-assisted extraction
- Manganese and copper-coated nickel oxide nanoparticles synthesized from Carica papaya leaf extract induce antimicrobial activity and breast cancer cell death by triggering mitochondrial caspases and p53
- Insight into heating method and Mozafari method as green processing techniques for the synthesis of micro- and nano-drug carriers
- Silicotungstic acid supported on Bi-based MOF-derived metal oxide for photodegradation of organic dyes
- Synthesis and characterization of capsaicin nanoparticles: An attempt to enhance its bioavailability and pharmacological actions
- Synthesis of Lawsonia inermis-encased silver–copper bimetallic nanoparticles with antioxidant, antibacterial, and cytotoxic activity
- Facile, polyherbal drug-mediated green synthesis of CuO nanoparticles and their potent biological applications
- Zinc oxide-manganese oxide/carboxymethyl cellulose-folic acid-sesamol hybrid nanomaterials: A molecularly targeted strategy for advanced triple-negative breast cancer therapy
- Exploring the antimicrobial potential of biogenically synthesized graphene oxide nanoparticles against targeted bacterial and fungal pathogens
- Biofabrication of silver nanoparticles using Uncaria tomentosa L.: Insight into characterization, antibacterial activities combined with antibiotics, and effect on Triticum aestivum germination
- Membrane distillation of synthetic urine for use in space structural habitat systems
- Investigation on mechanical properties of the green synthesis bamboo fiber/eggshell/coconut shell powder-based hybrid biocomposites under NaOH conditions
- Green synthesis of magnesium oxide nanoparticles using endophytic fungal strain to improve the growth, metabolic activities, yield traits, and phenolic compounds content of Nigella sativa L.
- Estimation of greenhouse gas emissions from rice and annual upland crops in Red River Delta of Vietnam using the denitrification–decomposition model
- Synthesis of humic acid with the obtaining of potassium humate based on coal waste from the Lenger deposit, Kazakhstan
- Ascorbic acid-mediated selenium nanoparticles as potential antihyperuricemic, antioxidant, anticoagulant, and thrombolytic agents
- Green synthesis of silver nanoparticles using Illicium verum extract: Optimization and characterization for biomedical applications
- Antibacterial and dynamical behaviour of silicon nanoparticles influenced sustainable waste flax fibre-reinforced epoxy composite for biomedical application
- Optimising coagulation/flocculation using response surface methodology and application of floc in biofertilisation
- Green synthesis and multifaceted characterization of iron oxide nanoparticles derived from Senna bicapsularis for enhanced in vitro and in vivo biological investigation
- Potent antibacterial nanocomposites from okra mucilage/chitosan/silver nanoparticles for multidrug-resistant Salmonella Typhimurium eradication
- Trachyspermum copticum aqueous seed extract-derived silver nanoparticles: Exploration of their structural characterization and comparative antibacterial performance against gram-positive and gram-negative bacteria
- Microwave-assisted ultrafine silver nanoparticle synthesis using Mitragyna speciosa for antimalarial applications
- Green synthesis and characterisation of spherical structure Ag/Fe2O3/TiO2 nanocomposite using acacia in the presence of neem and tulsi oils
- Green quantitative methods for linagliptin and empagliflozin in dosage forms
- Enhancement efficacy of omeprazole by conjugation with silver nanoparticles as a urease inhibitor
- Residual, sequential extraction, and ecological risk assessment of some metals in ash from municipal solid waste incineration, Vietnam
- Green synthesis of ZnO nanoparticles using the mangosteen (Garcinia mangostana L.) leaf extract: Comparative preliminary in vitro antibacterial study
- Simultaneous determination of lesinurad and febuxostat in commercial fixed-dose combinations using a greener normal-phase HPTLC method
- A greener RP-HPLC method for quaternary estimation of caffeine, paracetamol, levocetirizine, and phenylephrine acquiring AQbD with stability studies
- Optimization of biomass durian peel as a heterogeneous catalyst in biodiesel production using microwave irradiation
- Thermal treatment impact on the evolution of active phases in layered double hydroxide-based ZnCr photocatalysts: Photodegradation and antibacterial performance
- Preparation of silymarin-loaded zein polysaccharide core–shell nanostructures and evaluation of their biological potentials
- Preparation and characterization of composite-modified PA6 fiber for spectral heating and heat storage applications
- Preparation and electrocatalytic oxygen evolution of bimetallic phosphates (NiFe)2P/NF
- Rod-shaped Mo(vi) trichalcogenide–Mo(vi) oxide decorated on poly(1-H pyrrole) as a promising nanocomposite photoelectrode for green hydrogen generation from sewage water with high efficiency
- Green synthesis and studies on citrus medica leaf extract-mediated Au–ZnO nanocomposites: A sustainable approach for efficient photocatalytic degradation of rhodamine B dye in aqueous media
- Cellulosic materials for the removal of ciprofloxacin from aqueous environments
- The analytical assessment of metal contamination in industrial soils of Saudi Arabia using the inductively coupled plasma technology
- The effect of modified oily sludge on the slurry ability and combustion performance of coal water slurry
- Eggshell waste transformation to calcium chloride anhydride as food-grade additive and eggshell membranes as enzyme immobilization carrier
- Synthesis of EPAN and applications in the encapsulation of potassium humate
- Biosynthesis and characterization of silver nanoparticles from Cedrela toona leaf extracts: An exploration into their antibacterial, anticancer, and antioxidant potential
- Enhancing mechanical and rheological properties of HDPE films through annealing for eco-friendly agricultural applications
- Immobilisation of catalase purified from mushroom (Hydnum repandum) onto glutaraldehyde-activated chitosan and characterisation: Its application for the removal of hydrogen peroxide from artificial wastewater
- Sodium titanium oxide/zinc oxide (STO/ZnO) photocomposites for efficient dye degradation applications
- Effect of ex situ, eco-friendly ZnONPs incorporating green synthesised Moringa oleifera leaf extract in enhancing biochemical and molecular aspects of Vicia faba L. under salt stress
- Biosynthesis and characterization of selenium and silver nanoparticles using Trichoderma viride filtrate and their impact on Culex pipiens
- Photocatalytic degradation of organic dyes and biological potentials of biogenic zinc oxide nanoparticles synthesized using the polar extract of Cyperus scariosus R.Br. (Cyperaceae)
- Assessment of antiproliferative activity of green-synthesized nickel oxide nanoparticles against glioblastoma cells using Terminalia chebula
- Chlorine-free synthesis of phosphinic derivatives by change in the P-function
- Anticancer, antioxidant, and antimicrobial activities of nanoemulsions based on water-in-olive oil and loaded on biogenic silver nanoparticles
- Study and mechanism of formation of phosphorus production waste in Kazakhstan
- Synthesis and stabilization of anatase form of biomimetic TiO2 nanoparticles for enhancing anti-tumor potential
- Microwave-supported one-pot reaction for the synthesis of 5-alkyl/arylidene-2-(morpholin/thiomorpholin-4-yl)-1,3-thiazol-4(5H)-one derivatives over MgO solid base
- Screening the phytochemicals in Perilla leaves and phytosynthesis of bioactive silver nanoparticles for potential antioxidant and wound-healing application
- Graphene oxide/chitosan/manganese/folic acid-brucine functionalized nanocomposites show anticancer activity against liver cancer cells
- Nature of serpentinite interactions with low-concentration sulfuric acid solutions
- Multi-objective statistical optimisation utilising response surface methodology to predict engine performance using biofuels from waste plastic oil in CRDi engines
- Microwave-assisted extraction of acetosolv lignin from sugarcane bagasse and electrospinning of lignin/PEO nanofibres for carbon fibre production
- Biosynthesis, characterization, and investigation of cytotoxic activities of selenium nanoparticles utilizing Limosilactobacillus fermentum
- Highly photocatalytic materials based on the decoration of poly(O-chloroaniline) with molybdenum trichalcogenide oxide for green hydrogen generation from Red Sea water
- Highly efficient oil–water separation using superhydrophobic cellulose aerogels derived from corn straw
- Beta-cyclodextrin–Phyllanthus emblica emulsion for zinc oxide nanoparticles: Characteristics and photocatalysis
- Assessment of antimicrobial activity and methyl orange dye removal by Klebsiella pneumoniae-mediated silver nanoparticles
- Influential eradication of resistant Salmonella Typhimurium using bioactive nanocomposites from chitosan and radish seed-synthesized nanoselenium
- Antimicrobial activities and neuroprotective potential for Alzheimer’s disease of pure, Mn, Co, and Al-doped ZnO ultra-small nanoparticles
- Green synthesis of silver nanoparticles from Bauhinia variegata and their biological applications
- Synthesis and optimization of long-chain fatty acids via the oxidation of long-chain fatty alcohols
- Eminent Red Sea water hydrogen generation via a Pb(ii)-iodide/poly(1H-pyrrole) nanocomposite photocathode
- Green synthesis and effective genistein production by fungal β-glucosidase immobilized on Al2O3 nanocrystals synthesized in Cajanus cajan L. (Millsp.) leaf extracts
- Green stability-indicating RP-HPTLC technique for determining croconazole hydrochloride
- Green synthesis of La2O3–LaPO4 nanocomposites using Charybdis natator for DNA binding, cytotoxic, catalytic, and luminescence applications
- Eco-friendly drugs induce cellular changes in colistin-resistant bacteria
- Tangerine fruit peel extract mediated biogenic synthesized silver nanoparticles and their potential antimicrobial, antioxidant, and cytotoxic assessments
- Green synthesis on performance characteristics of a direct injection diesel engine using sandbox seed oil
- A highly sensitive β-AKBA-Ag-based fluorescent “turn off” chemosensor for rapid detection of abamectin in tomatoes
- Green synthesis and physical characterization of zinc oxide nanoparticles (ZnO NPs) derived from the methanol extract of Euphorbia dracunculoides Lam. (Euphorbiaceae) with enhanced biosafe applications
- Detection of morphine and data processing using surface plasmon resonance imaging sensor
- Effects of nanoparticles on the anaerobic digestion properties of sulfamethoxazole-containing chicken manure and analysis of bio-enzymes
- Bromic acid-thiourea synergistic leaching of sulfide gold ore
- Green chemistry approach to synthesize titanium dioxide nanoparticles using Fagonia Cretica extract, novel strategy for developing antimicrobial and antidiabetic therapies
- Green synthesis and effective utilization of biogenic Al2O3-nanocoupled fungal lipase in the resolution of active homochiral 2-octanol and its immobilization via aluminium oxide nanoparticles
- Eco-friendly RP-HPLC approach for simultaneously estimating the promising combination of pentoxifylline and simvastatin in therapeutic potential for breast cancer: Appraisal of greenness, whiteness, and Box–Behnken design
- Use of a humidity adsorbent derived from cockleshell waste in Thai fried fish crackers (Keropok)
- One-pot green synthesis, biological evaluation, and in silico study of pyrazole derivatives obtained from chalcones
- Bio-sorption of methylene blue and production of biofuel by brown alga Cystoseira sp. collected from Neom region, Kingdom of Saudi Arabia
- Synthesis of motexafin gadolinium: A promising radiosensitizer and imaging agent for cancer therapy
- The impact of varying sizes of silver nanoparticles on the induction of cellular damage in Klebsiella pneumoniae involving diverse mechanisms
- Microwave-assisted green synthesis, characterization, and in vitro antibacterial activity of NiO nanoparticles obtained from lemon peel extract
- Rhus microphylla-mediated biosynthesis of copper oxide nanoparticles for enhanced antibacterial and antibiofilm efficacy
- Harnessing trichalcogenide–molybdenum(vi) sulfide and molybdenum(vi) oxide within poly(1-amino-2-mercaptobenzene) frameworks as a photocathode for sustainable green hydrogen production from seawater without sacrificial agents
- Magnetically recyclable Fe3O4@SiO2 supported phosphonium ionic liquids for efficient and sustainable transformation of CO2 into oxazolidinones
- A comparative study of Fagonia arabica fabricated silver sulfide nanoparticles (Ag2S) and silver nanoparticles (AgNPs) with distinct antimicrobial, anticancer, and antioxidant properties
- Visible light photocatalytic degradation and biological activities of Aegle marmelos-mediated cerium oxide nanoparticles
- Physical intrinsic characteristics of spheroidal particles in coal gasification fine slag
- Exploring the effect of tea dust magnetic biochar on agricultural crops grown in polycyclic aromatic hydrocarbon contaminated soil
- Crosslinked chitosan-modified ultrafiltration membranes for efficient surface water treatment and enhanced anti-fouling performances
- Study on adsorption characteristics of biochars and their modified biochars for removal of organic dyes from aqueous solution
- Zein polymer nanocarrier for Ocimum basilicum var. purpurascens extract: Potential biomedical use
- Green synthesis, characterization, and in vitro and in vivo biological screening of iron oxide nanoparticles (Fe3O4) generated with hydroalcoholic extract of aerial parts of Euphorbia milii
- Novel microwave-based green approach for the synthesis of dual-loaded cyclodextrin nanosponges: Characterization, pharmacodynamics, and pharmacokinetics evaluation
- Bi2O3–BiOCl/poly-m-methyl aniline nanocomposite thin film for broad-spectrum light-sensing
- Green synthesis and characterization of CuO/ZnO nanocomposite using Musa acuminata leaf extract for cytotoxic studies on colorectal cancer cells (HCC2998)
- Review Articles
- Materials-based drug delivery approaches: Recent advances and future perspectives
- A review of thermal treatment for bamboo and its composites
- An overview of the role of nanoherbicides in tackling challenges of weed management in wheat: A novel approach
- An updated review on carbon nanomaterials: Types, synthesis, functionalization and applications, degradation and toxicity
- Special Issue: Emerging green nanomaterials for sustainable waste management and biomedical applications
- Green synthesis of silver nanoparticles using mature-pseudostem extracts of Alpinia nigra and their bioactivities
- Special Issue: New insights into nanopythotechnology: current trends and future prospects
- Green synthesis of FeO nanoparticles from coffee and its application for antibacterial, antifungal, and anti-oxidation activity
- Dye degradation activity of biogenically synthesized Cu/Fe/Ag trimetallic nanoparticles
- Special Issue: Composites and green composites
- Recent trends and advancements in the utilization of green composites and polymeric nanocarriers for enhancing food quality and sustainable processing
- Retraction
- Retraction of “Biosynthesis and characterization of silver nanoparticles from Cedrela toona leaf extracts: An exploration into their antibacterial, anticancer, and antioxidant potential”
- Retraction of “Photocatalytic degradation of organic dyes and biological potentials of biogenic zinc oxide nanoparticles synthesized using the polar extract of Cyperus scariosus R.Br. (Cyperaceae)”
- Retraction to “Green synthesis on performance characteristics of a direct injection diesel engine using sandbox seed oil”